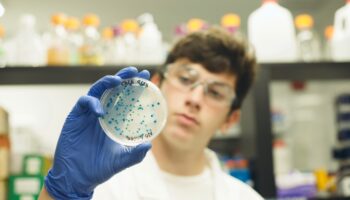
student holding a KnockOut lab plate

Welcome to our Blog
From lab tips to classroom resources, we've got it all. Pick a category to explore below.
- All
- Biology and biotech education
- Equipment selection
- Genes in Space
- Lab Tips
- Meet a scientist
- miniPCR applications
- miniPCR Digital
- News and announcements
Biotechnology techniques and tools are used across a variety of fields, including basic biology, healthcare, agriculture, forensics, and more! Introducing students to biotech skills through hands-on activities makes for engaging lessons in any life sciences classroom. Whether you are using gel electrophoresis in a forensics class to analyze DNA evidence or PCR to better understand […]
Sasha Krol, Alkermes Alkermes is a biopharmaceutical company that develops medicines designed to help people living with complex and difficult-to-treat psychiatric and neurological disorders. Dr. Sasha Krol is a Senior Scientist at Alkermes who uses CRISPR in her work to identify potential drug targets. Can you summarize your educational background? I have always been fascinated […]
Screen model organisms with maximal efficiency using the new BEAM™ fluorescence module! BEAM transforms standard stereo microscopes into fluorescence microscopes, providing a cost-effective and compact method for rapid visualization of Drosophila, C. elegans, Zebrafish, Arabidopsis, and more. Give your research lab a glow up! In a collaborative and busy research environment, shared equipment can be […]
At miniPCR bio, we are on a mission to make science accessible to everyone, everywhere. Whether you are setting up a lab in Europe, running an educational workshop in South America, or conducting fieldwork in Asia, we want to ensure your ordering process is as seamless as possible. Because global shipping involves strict logistics, customs regulations, […]
Bring wildlife ecology and DNA testing to life in your classroom with the Shark Lab: Great White Migration! Similar-looking fins from white sharks have been spotted in four different locations around the globe. In this gel electrophoresis lab, students use DNA fingerprinting to identify individual sharks and determine if they are migrating across oceans! This […]
Join Dr. Lydia Greene on May 26th, at 3 PM EST as she introduces the new Shark Lab: Great White Migration. This 30-minute webinar will explain how teachers can bring wildlife ecology to life in their classrooms! In this webinar, we will demonstrate how your students use DNA fingerprinting to confirm the identity of white […]
Adding biotech to your life sciences curriculum is a powerful enabler for classrooms of all levels, but figuring out which equipment to get, and how much of each, can be daunting. With miniPCR bio Classroom Packs we have done the legwork for you already — use the tables below to select the pack that best […]
The DNA Glow Lab is one of miniPCR bio’s most popular biology labs, as it allows students to directly visualize DNA denaturing and re-annealing to form base pairs – right in the palm of their hand! We have given the DNA Glow Lab its own “glow-up” — with updated curriculum, streamlined experimental protocols, and a […]
We’re excited to share the newest addition to the miniPCR Digital library: the True Blue Digital Lab. Adapted from our popular hands-on True Blue Transformation Lab, this online simulation is a great resource to add to your teaching toolkit, whether you’re running a hands-on bacterial transformation lab in class, or time and resources call for […]
Biotech plays an essential role in biomedical, clinical, and medical laboratory science. Engage your students with hands-on lab activities from miniPCR bio based on real-world biomedical tests! Here’s a summary of the biotech labs that can align with different topics in your lab course curriculum: Practice basic lab skills: Micropipetting: mastering micropipetting is an essential […]
The BEAM™ fluorescence module transforms your classroom stereo microscopes into fluorescence microscopes, allowing your students to visualize and explore fluorescent objects and organisms such as Drosophila, C. elegans, zebrafish, Arabidopsis, and more. Give your classroom a glow up! Fluorescence microscopes have historically been extraordinarily expensive and far beyond the reach of high school and college […]
Farmers often need to select hens to optimize egg production, and DNA testing can accurately identify chicken sex, even before the eggs hatch. The ZeeWee™ I Bird DNA Test is a great hands-on lab experience for the classroom, offering students the chance to run a real-world DNA test on authentic chicken samples. Reasons to bring […]
Join Dr. Ally Huang on April 13, at 3 PM EST as she introduces the newly updated DNA Glow Lab™: Exploring DNA Structure. This 45-minute webinar will explain how teachers can effectively integrate a visually engaging activity to study DNA structure. In this webinar, we will demonstrate how your students investigate base pairing and double-helix stability using […]
An engaging, hands-on lab activity to teach the fundamentals of DNA structure DNA structure and complementary base pairing are essential concepts in biology, but there are very few, if any, authentic hands-on lab activities to engage students with this content. The DNA Glow Lab from miniPCR bio lets you move beyond static DNA models and […]
DNA testing is the most accurate way to determine the sex of your avian friends. To help you get it right, we offer a variety of kits, each one optimized for different bird species. How to Choose the Correct Sexing Kit Primers are the key to DNA tests. They are short, single-stranded DNA sequences that […]
Bandit Duo™: Integrated DNA gel electrophoresis at a fraction of the cost For many educators and researchers, one of the largest hurdles is overcoming budget constraints. At miniPCR bio, we’re committed to making biotech accessible by offering reliable, affordable tools for the classroom and lab. Skip bulky, expensive electrophoresis systems and run DNA gels on-the-go. […]
While our chicken DNA tests typically use blood or feather samples, eggshell membrane sampling can be a helpful alternative. This guide will explain why you might want to use eggshell samples and how to collect their DNA. Why use eggshell membranes? Eggshell membrane sampling is ideal when you want to test chicks immediately after hatching […]
miniPCR Digital is an e-learning platform that offers narrative-driven virtual labs in a classroom-ready environment. Students work through real experimental scenarios with biotechnology — analyzing data, making predictions, and interpreting results — while teachers monitor progress and check understanding through autograded assessments. Through miniPCR Digital, we hope to further broaden access to science by enabling […]
In this short video from the Sickle Cell Genetics Digital Lab, we introduce students to sickle cell disease: a relatively common genetic disorder caused by a straightforward molecular change. A single base-pair mutation leads to a dramatic and observable change in red blood cell shape. Because it so clearly links genotype to phenotype, sickle cell […]
Biotechnology and molecular diagnostics are no longer confined to academic labs. They are also essential tools in daily agricultural activities for: Pathogen surveillance and antibiotic tracking: Farmers can monitor livestock and plant health. These preventative measures guarantee food safety and screen for potential pathogenic outbreaks. GMO and species identification: Producers can ensure transparency and quality […]
¿Quién debería tener acceso al poder de la biotecnología? Esta fue la pregunta central de la charla de Sebastian Kraves, cofundador de miniPCR bio, en el prestigioso evento Congreso Futuro. Durante su presentación, el Dr. Kraves compartió la visión que dio origen a nuestra misión: sacar la ciencia de los laboratorios convencionales y ponerla directamente […]
This notice, intended for miniPCR mini8 thermal cycler users who rely on a Chromebook connection, addresses the consequences of Google’s announced phasing out of Chrome Apps (legacy Chrome Web Store apps). Please disregard this notice if ANY of the following apply to you: You are NOT a mini8 thermal cycler owner (i.e., you use mini8X, […]
Preparing students for the HOSA Biotechnology competition doesn’t have to be daunting, even if you’re new to the skills. miniPCR bio provides affordable equipment and free resources to help your students be confident at the lab bench. To start, we recommend focusing on these essential HOSA biotechnology skills: Skill I: Using Micropipetting Micropipetting is the […]
To the Ones Who Started the Revolution: A Thank You to Our Backers When we started miniPCR bio in a cold Boston basement in 2013, we had a prototype and a big question: What happens when you take biotechnology out of the ivory tower and put it into the hands of everyone? In a recent […]
New year, new products, same commitment to accessibility. Discover entirely new products, improvements to popular titles, and a continued commitment to empowering everyone with accessible biotechnology. Dive into our 2026 catalog, and expand your curiosity! Highlights from the 2026 Catalog: Continued Innovation in Accessible Biotech Since our last catalog edition, we’ve officially launched over 5 […]
Overwhelmed by trying to plan a biotech course? miniPCR’s team of biotech education experts is here to help! The new miniPCR® biotech course builder allows you to quickly and confidently design a customized biotech course in minutes. Just follow five simple steps: 1. Go to the miniPCR® Biotech Hub and scroll down to “Design […]
Imagine you are running an experiment and when you look at the results, you see….nothing? What could have happened? Maybe your lab equipment malfunctioned, or you made a mistake following the lab protocol. Or everything went right, and this is the actual experimental result. Including the right experimental controls will allow you to be more […]
Micropipetting is the foundational skill on which many biological experiments are based! Micropipettes enable scientists to measure small volumes precisely and are essential tools in molecular biology labs. Here are tips for micropipetting success! 1. How to select the right micropipette: Micropipettes are commonly available in four volume ranges, usually labeled on the barrel or […]
Hands-on science experiments like growing bacteria can spark student interest in science, but the cost of specialized laboratory equipment can sometimes be prohibitive. This post will cover three low-cost ways to grow bacteria in the classroom without a standard laboratory incubator. 1. Grow bacteria at room temperature. In many cases, you don’t need an incubator […]
Introducing the Cozy Cube™ Incubator — a budget-friendly device to grow bacteria efficiently. The perfect partner for microbiology work and biochemical reactions, both in the classroom and in professional labs. The Cozy Cube™ incubator offers a stable 37 ºC temperature for bacterial growth on plates or liquid media, routine microorganism culturing, and enzymatic reactions. Just […]
Gel electrophoresis is one of the most exciting laboratory techniques you can introduce to a classroom. Not only can watching the migration of molecules across a gel be engaging, but it’s also a powerful teaching tool to explore fundamental biology concepts. Dye Electrophoresis Learning Labs utilize safe and affordable dye samples, making it easier than […]
miniPCR bio was founded on the principle of making science accessible to everyone, everywhere. One of the major areas we aim to increase access to is science education. This means designing a range of curricular materials to facilitate biotechnology integration into classrooms at any level. The essential goal of the curriculum team at miniPCR bio […]
On Monday, November 17 at 3PM ET, join Dr. Katy Martin as she demonstrates our popular BioBits® Central Dogma Lab. With updated curriculum including new extensions and digital tools, this one-of-a-kind lab allows you to layer experimentation into your coverage of the Central Dogma, no matter what level you teach. This free, 45-minute webinar will […]
The BioBits®: Central Dogma Lab is one of miniPCR bio’s most popular high-school biology labs – and it’s easy to see why! This engaging, hands-on genetics activity enables students to directly visualize the flow of genetic information—from DNA to RNA to protein—with easy teacher prep and a simple student lab protocol. We’ve made the Central […]
Join Dr. Kristin Hennessy-McDonald on October 30, at 3 PM EST as she introduces the Hemophilia Genetics Lab: X-Linked Inheritance Learning Lab. This 45-minute webinar will explain how teachers can effectively integrate gel electrophoresis into their teaching of non-Mendelian inheritance. In this webinar, we will demonstrate how your students can step into the role of […]
We’re excited to share our newest interactive resource: the Sickle Cell Genetics Digital Lab. Adapted from our popular hands-on Learning Lab, this online simulation is a great resource to add to your teaching toolkit, whether you’re running the hands-on version in class, or time and resources call for an accessible alternative. This virtual lab immerses […]
In the sprawling rural landscape of Silverton, Oregon, one 6th-8th-grade teacher, Mrs. Marshall is redefining hands-on learning, proving that science is for everyone, everywhere. With a passion for both education and her backyard farm, Mrs. Marshall has cultivated a unique agricultural program that not only teaches students about animal care but also equips them with […]
Over 12 years ago, our company began with a simple vision: to make molecular biology accessible to everyone. We built the very first prototypes, and even a few production units, in a basement in Cambridge, MA. With the incredible support of our Kickstarter community, what began as a passion project grew into a thriving company. […]
Uncover the power of genetic testing through a hands-on classroom experience designed to bring non-Mendelian inheritance to life. In this lab, your students step into the role of a physician treating baby Andrew, a newborn recently diagnosed with hemophilia A, an X-linked bleeding disorder caused by a mutation in the F8 gene. Their mission? To […]
If you know miniPCR bio, you know our mission: making the powerful tools of modern biotechnology accessible, portable, and easy to use—whether in classrooms, labs, or even outer space. But did you know we also have a genetic testing solutions arm? That’s miniPCR Dx. While miniPCR bio focuses on research, fieldwork, STEM education, and training, […]
Join Dr. Kristin Hennessy-McDonald on September 30, at 3 PM EST as she introduces the Food Safety Lab: Food Truck Trouble Learning Lab. This 60-minute webinar will explain how teachers can effectively integrate the biotechnology techniques of PCR, restriction digestion, and gel electrophoresis. Students step into the shoes of a public health scientist solving a food-poisoning […]
Many tests and one bundle to rule them all! The strength of miniPCR Dx gelPCR bundles is that a single bundle opens the door to countless genotyping possibilities. Whether you’re a ball python breeder screening new hatchlings for a range of recessive traits, or a passionate fowl breeder selecting for sex and desirable traits within the […]
An outbreak of foodborne illness linked to pathogenic E. coli has hit a food truck festival! Vomiting, abdominal cramps, and bloody diarrhea are the symptoms, and it’s up to your students to find the source. With the newly updated “Food Safety Lab: Food Truck Trouble!” kit (KT-1001-04) from miniPCR bio™, students step into the role of public health detectives, […]
This week, we shipped the first Lab in a Box biotechnology equipment loan of the 2025-2026 school year! This is the first of 35 loans that are scheduled to ship this year. Through Lab in a Box, teachers across 20 states will be able to bring DNA technology into their classrooms, giving many of their […]
Antibiotic resistance is one of the most pressing public health crises of our time, responsible for millions of deaths worldwide. For decades, the pace of new antibiotic development has slowed dramatically, leaving us with a dwindling arsenal against a growing threat. Researchers at MIT and Harvard, in a study published in Cell, are tackling this […]
The AP Biology Course and Exam Description (CED) has been updated, with the new standards taking effect in the 2025–2026 school year. While biotechnology remains listed as Topic 6.8, it cannot be effectively taught as a single, standalone unit. Biotechnology is integral to scientific discovery, and as AP Biology students learn to investigate and answer […]
If your students just wrapped up the miniPCR PTC Taster Learning Lab, this quick video is the perfect next step. It walks them through gel interpretation using clear visuals and simple explanations, helping them connect DNA banding patterns to genotypes. Whether your students are new to gel electrophoresis or just need a confidence boost, this […]
In this short video, we explore an interesting wrinkle in the PTC Taster Learning Lab: what is happening when a student’s taster phenotype doesn’t align with their TAS2R38 genotype? While most students will see a clear match between their genotype and their ability to taste PTC, a small minority may not — offering you a […]
Advanced Placement (AP®*) Biology, developed by the College Board, is a rigorous and wide-ranging curriculum that requires students to develop a deep understanding of core concepts. Because online resources incorporate a wide range of engaging instructional approaches, they can offer a more effective way for students to build understanding. miniPCR Digital Labs provide interactive virtual [...]
Science education is all about helping students engage with complex concepts in ways that are meaningful and memorable. For many teachers, miniPCR Digital has become a valuable tool for making that happen, whether students have access to a full lab or are learning remotely. Since launching our first Digital Lab, we’ve collected feedback from countless […]
PCR is a very sensitive technique that allows amplification of target sequences from very small amounts of input DNA. However, this sensitivity also makes PCR prone to contamination. Contamination may lead to incorrect data interpretation and false positive results. This summary explains the causes of PCR contamination and presents effective strategies to prevent it. What […]
Students at Essex North Shore Agricultural & Technical School practice on-farm chicken diagnostics For centuries, farmers and breeders have used selective breeding to enhance desirable traits in crops and livestock. Today, molecular diagnostics accelerates the process, enabling rapid, on-farm DNA testing. With user-friendly DNA testing kits, breeders can analyze genetic traits in real time and [...]
On Monday, April 14 at 3PM ET, join Curriculum Specialist Rose Chaffee-Cohen as she guides you through miniPCR bio’s newly updated Sickle Cell Genetics Lab: Diagnosing Baby Marie. This hands-on gel electrophoresis lab ties together genetic testing, structure and function, inheritance, natural selection, and CRISPR/Cas gene therapies! This 45-minute webinar is free and open to […]
DNA analysis tool adds portable power and enhanced speed, sensitivity Cambridge, MA – April 2, 2025 – miniPCR bio™ proudly announces the launch of its latest innovation, the newly redesigned blueGel™ Electrophoresis System, the latest addition to the company’s electrophoresis portfolio, which also includes the GELATO™ professional system and the Bandit™ electrophoresis STEM kit. Crafted with […]
On Monday, April 7 at 3PM ET, join Lead Research Scientist Ally Huang as she guides you through miniPCR’s new Protein Expression and Purification Lab. Express a mix of fluorescent proteins and watch as you purify them – with magnets! Using cell-free technology and magnetic beads, this classroom-friendly lab gives students hands-on experience with the essential biotech […]
Not all white chickens are the same—white plumage can result from different genetic mutations. Understanding the specific genes your chickens carry allows for better flock selection and informed breeding decisions. The genetics behind recessive white Recessive white in chickens results from a mutation in the TYR gene, which plays a key role in producing melanin—the […]
A retrovirus is the genetic element that makes chicken eggshells blue – and you can test for it at home! With egg shortages becoming more common, many people are turning to backyard chickens for a steady, reliable supply. Not only does keeping chickens ensure fresh eggs, but it also allows you to select for unique and […]
The 2025 NSTA National Conference is only 1 week away! miniPCR is ready to showcase innovative tools and resources that transform science education. Will you be there? Don’t wait—register now and join us in Philadelphia! #NSTASpring25 In addition to meeting us at booth 617, join us for two days of hands-on biotech professional development workshops in Room […]
Gregor Mendel wasn’t your typical scientific rebel. He wasn’t shaking up the world in a grand laboratory or defying authority—he was a monk, quietly tending his pea plants in a monastery garden. Yet, in that solitude, he uncovered the fundamental laws of heredity, long before anyone knew about DNA. Mendel’s law of segregation showed that […]
miniPCR Digital Labs have officially launched, offering an innovative approach to science education through interactive, narrative-driven simulations and integrated hands-on experiments. Designed to engage students in molecular biology and biotechnology, these labs bring complex concepts to life in ways that are both accessible and exciting. Here, miniPCR Digital Initiatives Lead Katy Martin shares the inspiration […]
Are you looking for a way to bring hands-on biotechnology into your classroom? Do you want expert-led professional development tailored to your needs—all without leaving your school? The miniPCR Virtual Workshops offer an incredible opportunity for educators to gain hands-on training in cutting-edge biotechnology while receiving accessible biotech tools to use in their classrooms. Expert […]
On Monday, February 24 at 3PM ET, join Curriculum Specialist Rose Chaffee-Cohen as she guides you through Knockout! A CRISPR/Cas Gene Targeting Learning Lab. This lab allows students to use CRISPR/Cas to disrupt a gene in bacteria and observe a dramatic phenotypic change! Simple teacher prep, streamlined student protocol, and great transformation efficiency make this […]
We’re excited to announce the launch of the Central Dogma Digital Lab, an interactive virtual lab that brings the central dogma of molecular biology to life. Whether students are pipetting at the bench or exploring genetics in a fully virtual setting, this new Digital Lab offers an engaging, narrative-driven experience that helps them visualize and […]
Our Princes in the Tower dye electrophoresis Learning Lab brings modern DNA technology to an ancient mystery: What happened to Princes Edward and Richard, the heirs to the English throne who vanished in 1483? In this post, we’ll explore how DNA analysis helps identify human remains. Why is DNA used for forensic analysis of human […]
We are pleased to announce the PTC Taster Digital Lab: a powerful new tool for bringing genetics to life in the classroom. Based on our bestselling PTC Taster Learning Lab, this interactive, narrative-driven virtual lab makes it easy to engage students in authentic scientific inquiry—with or without lab equipment. Why use the PTC Taster Digital […]
miniPCR Digital Lab Simulations are interactive virtual resources that guide students through the experience of conducting an experiment—without any hands-on component. These simulations provide an authentic lab experience, allowing students to design experiments, collect and analyze data, and draw conclusions—all in a fully digital environment. Whether you’re facing resource limitations, time constraints, or student absences, […]
miniPCR Digital Lab Companions are interactive virtual resources designed to enhance student engagement while guiding them through a hands-on miniPCR Learning Lab. These digital resources offer structured guidance, immediate feedback, and built-in assessment tools—all in one place. If you’re still relying on traditional printed lab manuals, here are four compelling reasons to consider making the […]
Science education is at its best when it’s hands-on, but what if your classroom doesn’t have access to a lab? Or what if you’re learning from home? That’s why we’re so excited to introduce miniPCR Digital, our new interactive learning platform that brings the thrill of discovery to your fingertips. With miniPCR Digital Labs, students […]
Unexpectedly finding Mbola’s cousins out West By: Marina Blanco & Lydia Greene Collaborators: Sebastian Kraves & Ezequiel Alvarez-Saavedra (miniPCR bio); Toky Rakotoarinivo, Rova Ramaroson, & Josia Razafindramanana (IMPACT Madagascar); Fanomezana Ratsoavina (University of Antananarivo); Elaine Guevara (Duke University) Our story starts in the forests of Tsinjoarivo. Sitting on the eastern side of Madagascar’s central highlands, […]
Danielle Hardy, a backyard avian breeder, has seamlessly blended her passion for birds and science. Given the limited availability of efficient avian DNA testing within the breeding community, Danielle set up her own laboratory with the help of miniPCR. What began as a personal endeavor to better manage her own flock of chickens has evolved […]
This video explains the student progress monitoring tools available for teachers on miniPCR Digital. miniPCR Digital is an e-learning platform for experiment-based learning in the classroom. Explore our virtual lab simulations and hands-on lab companions at https://digital.minipcr.com. Related resources: How to create an account on miniPCR Digital How to log in to your miniPCR Digital [...]
This video explains the types of activities available on miniPCR Digital and walks you through the process of assigning activities to your students. miniPCR Digital is an e-learning platform for experiment-based learning in the classroom. Explore our virtual lab simulations and hands-on lab companions at https://digital.minipcr.com. Related resources: How to create an account on miniPCR […]
This video walks teachers though the process of creating classes and assigning activities on miniPCR Digital, and explains to students how they can join those classes. miniPCR Digital is an e-learning platform for experiment-based learning in the classroom. Explore our virtual lab simulations and hands-on lab companions at https://digital.minipcr.com. Related resources: How to create an account […]
This video walks you though the process of purchasing and using licenses to enable access to paid activities on miniPCR Digital. miniPCR Digital is an e-learning platform for experiment-based learning in the classroom. Explore our virtual lab simulations and hands-on lab companions at https://digital.minipcr.com. Related resources: How to create an account on miniPCR Digital How […]
This video walks you through the process of logging in to your miniPCR Digital account. miniPCR Digital is an e-learning platform for experiment-based learning in the classroom. Explore our virtual lab simulations and hands-on lab companions at https://digital.minipcr.com. Related resources: How to create an account on miniPCR Digital How to buy and use licenses for […]
This video walks you though the process of creating a teacher or student account on miniPCR Digital. miniPCR Digital is an e-learning platform for experiment-based learning in the classroom. Explore our virtual lab simulations and hands-on lab companions at https://digital.minipcr.com. Related resources: How to log in to your miniPCR Digital account How to buy and [...]
On Monday, January 27 at 3PM ET, join Curriculum Specialist Rose Chaffee-Cohen as she introduces our newest Learning Lab, Inherited Cancer Risk: Genetic Testing for Lynch Syndrome. In this gel electrophoresis lab, students perform genetic testing on members of a fictional family to identify whether they carry a mutation associated with increased cancer risk. Extensions […]
On Monday, January 13 at 3PM ET, join miniPCR bio curriculum specialist Dr. Kristin Hennessy-McDonald as she introduces our latest dye electrophoresis lab, the Princes in the Tower Lab. Based on one of the most enduring unsolved cases in English history, this webinar will explore using gel electrophoresis to carry out forensic DNA analysis on […]
miniPCR Digital has a new look. Built to give teachers a more engaging, more streamlined way to deliver hands-on and virtual labs, miniPCR Digital is now proud to offer its users new features, including: Improved user interface, including navigation shortcuts Performance Snapshot feature so teachers can quickly assess which concepts require clarification Additional Digital Labs […]
We are excited to announce the winner of the miniPCR bio Fall 2024 Conference Raffle! The winner will receive a classroom biotech package that includes: 8 blueGel electrophoresis systems 10 fixed-volume micropipettes 10 silicone practice gels 1 micropipette art activity kit 1 Sickle Cell Genetics Learning Lab kit with gel electrophoresis reagents And the winner is… Heather Green Middle Tennessee State University […]
Scientists use DNA gel electrophoresis to separate DNA fragments by size. An essential element of almost every gel electrophoresis experiment is the use of a DNA ladder or molecular weight marker that contains fragments of known sizes (molecular weights). How is band size determined on an electrophoresis gel? Comparing the migration distance of the DNA […]
With the Viewit™ Illumination Kit, you can see DNA separation in real time Gel electrophoresis is an essential biotech method that can engage students in topics across the biology curriculum, from genetics and human health to ecology and evolution. Now you can bring DNA gel electrophoresis to your classroom at an unbeatable price The Bandit™ […]
Don’t count your chickens before they hatch, DNA test them! Richard Rosenberger, a silkie breeder in the Netherlands, breeds about 100-150 hens annually. To select female chicks humanely, he developed a method to draw blood from eggs without harming embryos. He then extracts DNA from the blood to determine the sex using PCR, the polymerase […]
Genetic testing is not the future—it’s the present! Engage your students with a hands-on gel electrophoresis lab where they will analyze DNA samples from family members to diagnose Lynch syndrome, a hereditary cancer risk, and track the inheritance through pedigree analysis. Extend their learning with in-depth lab extensions on cancer drivers and bioethics, making the […]
miniPCR Learning Labs™ are generally compatible with equipment from other manufacturers. While miniPCR offers or own devices (like the miniPCR® thermal cycler and a broad range of electrophoresis systems), the reagents, protocols, and lab exercises included in our Learning Labs are designed to be versatile. You can use common lab equipment from other brands as long […]
In its latest update, the Texas Essential Knowledge and Skills (TEKS) Biology standards have been expanded to include an understanding of current biotechnology. While biotechnology is specifically listed in the updated TEKS standards (see topic B.7(D)), it’s important to note that biotechnology can be applied to impart a practical understanding of topics throughout the biology […]
Join us for two days of hands-on biotech professional development workshops at the NSTA National Conference in New Orleans! Our sessions are carefully designed to ensure educators are equipped with the latest techniques and resources to bring innovative biology learning into their classrooms. Don’t miss this opportunity to enhance your teaching toolkit and stay at […]
Over the past several years, forensics has become a go-to science elective, sure to engage science nerds and avowed nonscientists alike. And what’s not to love? Forensics is a great way to acquaint students with the real-life tools professionals use to solve scientific problems, including biotechnology. To help you introduce your students to the biology […]
Engage students in forensic DNA analysis by investigating a famous royal mystery In 1483, two English princes vanished, and their remains have never been found. Inspired by this real-life mystery, the Princes in the Tower dye electrophoresis lab introduces students to forensic DNA analysis. Students use gel electrophoresis to examine DNA from two pairs of […]
Investigation aims to validate rapid detection of RNA risks during spaceflight October 3rd, 2024 (KENNEDY SPACE CENTER, FL) – On Saturday, September 28th, an experiment designed by Genes in Space 2023 contest winner Isabel Jiang (18) of Hillsborough, California, launched to the International Space Station (ISS) aboard NASA’s Crew-9 mission. The first run of her investigation was performed […]
This week, the Lab in a Box program from Genes in Space reached an important milestone: Our 200th loan will be shipping to a high school in Utah! Nearly eight years ago, miniPCR bio founded the Genes in Space Lab in a Box program to help teachers deliver hands-on molecular biology experiences to students. The company began offering two-week […]
What is a gel electrophoresis buffer? A gel electrophoresis buffer is an electrolyte solution used in gel electrophoresis to provide a stable environment for the separation of nucleic acids. Salts in the buffer ensure that DNA molecules can move through the agarose gel matrix when an electric field is applied, while ions and counterions serve […]
miniPCR bio is pleased to once again sponsor the Undergraduate Genetics Education Network (UGEN) annual virtual workshop! Mark your calendars to ensure you don’t miss this exciting event. Check back soon for details on how to register.
Join us for three days of hands-on biotech professional development workshops at CAST 24 in San Antonio, Texas! Our sessions are carefully designed to align with the new Texas Essential Knowledge and Skills (TEKS) standards, ensuring educators are equipped with the latest techniques and resources to bring innovative life sciences learning into their classrooms. Don’t […]
Biotechnology thrives on harnessing the power of proteins. To make these proteins, scientists introduce DNA to cells in a culture to produce the protein they want—a process known as protein expression. These resulting proteins play important roles in countless applications. Here are just four (of many) important proteins that have helped solve problems and improve […]
Protein expression and purification as essential biotech skills Purified proteins play important roles in areas as diverse as medicine and biofuel production. To make these proteins, scientists introduce DNA to cells in a culture. These cells will produce the protein of interest from information encoded in the DNA—a process known as protein expression. Once the […]
Sarita Khanal Paudyal, AbCellera AbCellera develops antibody-based medicines. Sarita currently works on a team that expresses and purifies transmembrane proteins for use in the development of therapeutics. Has your career path taken any unexpected turns? I have a degree in business from my home country, Nepal, but I moved to South Korea with my family […]
Daria McCallum, New England Biolabs New England Biolabs is a world leader in the discovery and production of enzymes for molecular biology applications. Daria has played several roles at New England Biolabs, including more than six years working on protein production with a focus on purifying restriction endonucleases. What education or training did you complete […]
DNA sequencing is a laboratory technique that allows scientists to determine the order of the nucleotides within a region of DNA. DNA sequencing has revolutionized fields such as genetics, molecular biology, and medicine. In recent years, the accessibility of DNA sequencing technology has expanded beyond professional laboratories. Today, students in classrooms and hobbyists can prepare […]
Protein purification is an essential biotech method, but traditional column chromatography protocols tend to require a lot of class time and can be prohibitively expensive in an educational setting. Magnetic protein purification is a classroom-friendly alternative! Magnetic vs. column purification of proteins Many protein purification methods rely on beads designed to separate proteins based on […]
Micropipetting is a fundamental skill in molecular biology that demands precision, accuracy, and consistency. Whether you’re setting up PCR reactions, preparing serial dilutions, or measuring small volumes of reagents, the ability to pipette accurately can make or break your experiments. For those just starting, we have plenty of resources available to help you get the […]
Boston, Aug. 1, 2024 — Isabelle Chuang and Julia Gross, high school seniors from The Nightingale-Bamford School in New York, NY, have been named the national winners of the Genes in Space competition, a biology-based research competition co-founded by Boeing’s Space Exploration division and miniPCR bio. The announcement was made today at the International Space Station (ISS) […]
Career and Technology Education (CTE) programs are specialized educational pathways that equip students with the practical skills and knowledge needed for specific careers and industries. By providing technical training and opportunities to practice employability skills like teamwork, problem-solving, and communication, CTE prepares students for immediate entry into the workforce, further education, or advanced training. Biotechnology […]
Using the Pullit™ magnetic rack The Pullit™ magnetic rack is designed to help you use magnetic beads to purify molecules like DNA, RNA, or proteins. Placing tubes in the Pullit magnetic rack You can use the rounded side handles to hold the Pullit rack. The Pullit rack has holes and a shelf to position the […]
The traditional image of a molecular biologist is someone working at a lab bench pipetting, running gel electrophoresis, or purifying proteins. While these activities are still at the heart of molecular biology, more and more biologists are working not at the bench but at a computer, where they analyze the vast quantities of data generated […]
Gel electrophoresis is a fundamental technique in molecular biology used to separate DNA fragments. The blueGel system by miniPCR bio offers a safe, easy-to-use, and compact option for running gels in your lab or classroom. Let’s explore the different ways you can purchase the blueGel system to fit your needs: 1. Single blueGel Unit: Perfect […]
miniPCR bio offers three main gel electrophoresis systems: GELATO™, Bandit™, and blueGel™. They cater to different needs and experience levels: GELATO™ electrophoresis and visualization system GELATO is a high-end system designed for professional use or research labs that require publication quality results. It boasts several features: Large capacity gels: Run up to 50 DNA samples […]
What is Magnetic Separation? Magnetic beads are useful in many biology and biotechnology experiments for isolating target molecules or purifying proteins. Like other purification techniques, magnetic beads use a three-step process: bind, wash, and elute. But instead of relying on centrifugation or filters to separate the molecules, magnetic force comes into play. Magnetic beads can […]
Genes in Space National STEM Competition Finalists Compete to Launch Experiment to Space Winning student experiment will be carried out on the International Space Station May 20, 2024, Cambridge, MA – Five teams of high school students from across the nation were named Finalists in the Genes in Space annual science competition, which challenges students from […]
Dr. Sebastian Kraves is the co-founder of miniPCR bio, a company that simplifies complex scientific concepts for educational purposes. In this interview for the National Association of Science Teaching, Dr. Kraves discusses his passion for biology, which stemmed from reading Darwin’s Voyage of the Beagle at a young age. He talks about his work on […]
Don’t let the biology teachers have all the fun–use biotechnology in your AP Environmental Science (APES) classroom and show students how high-tech tools are used for environmental monitoring and to solve real-world problems! At miniPCR bio, we offer inquiry-based, hands-on lab investigations that explore a range of APES concepts like monitoring threatened animal populations, testing […]
Biomedical researchers know the importance of efficiency and safety in the lab. Traditional gel electrophoresis setups can be cumbersome, time-consuming, and require exposure to harmful UV light and DNA stains. The GELATO™ electrophoresis system from miniPCR bio is designed to optimize your workflow and prioritize safety. GELATO™ integrates gel electrophoresis with a safe, blue-light transilluminator […]
A major medical breakthrough arrived in the last days of 2023, as the U.S. Food and Drug Administration (FDA) approved the first CRISPR-based therapy for the treatment of sickle cell anemia. This advance brings new hope to the hundreds of thousands who struggle with the disorder. How to teach CRISPR gene therapy for sickle […]
DNA barcoding is a specific type of DNA analysis aimed at identifying different species. This can be used by citizen scientists who want to identify mushrooms from their local forests, by field researchers measuring biodiversity in a remote jungle, or by food safety experts monitoring for harmful bacterial outbreaks. In this blog post, we’ll break [...]
Bacterial transformation is the process in which bacteria take up DNA from their environment. In molecular biology labs, this technique is used to introduce into bacteria a DNA sequence of interest – typically, a plasmid. (To learn about the essential elements of plasmids, check out our blog post outlining the key features of plasmids.) If […]
Looking to get picture perfect gels? Here are some optimization tips for you. Gel electrophoresis is an essential biotech method and a great way to integrate hands-on biotech experiments into your classroom. But your students’ gels won’t always look perfect. In this post we cover two of the most common issues your students may encounter […]
Introducing the new “Request a Quote” feature at minipcr.com At miniPCR bio we are constantly striving to improve your experience and make it easier than ever to find the perfect products for your lab or classroom. That’s why we’re thrilled to announce the launch of the new “Request a Quote” feature on minipcr.com. Here’s how […]
In a newly released video, Dr. Sebastian Kraves, co-founder of miniPCR bio, discusses the importance of biotechnology education in classrooms and how our company's workshops can help educators. The interview was conducted by NSTA TV at the 2024 National Conference on Science Education in Denver, Colorado. At the conference, miniPCR bio offered workshops specifically designed [...]
Experiment was conducted on the International Space Station as part of the Genes in Space contest Cambridge, MA, March 15, 2024 – The high school student winner of the 2020 Genes in Space competition, Kristoff Misquitta (now 21), has published the results of his investigation in the open-access journal PLOS ONE. The publication validates the use of a […]
Cambridge, MA, March 6, 2024 – The student winner of the 2021 Genes in Space competition has published the results of her groundbreaking research investigation in the open-access journal ACS Synthetic Biology. Selin Kocalar (20), who developed the investigation as a high school student, used a technology known as cell-free protein synthesis (CFPS) to build environmental sensors that can be […]
Plasmids are small, circular pieces of DNA often found naturally in bacteria and other microorganisms. Independent from the bacterial chromosome, plasmids replicate autonomously and exist in multiple copies inside the host cell. Plasmids often contain genes that provide beneficial traits for the organism, for example antibiotic resistance. In molecular biology laboratories, plasmids can serve to [...]
Unveiling the Artistic Side of Science Micropipetting, the process of transferring tiny volumes of liquids, is a fundamental skill in biology labs. But who knew it could also be an artistic outlet? A micropipetting art activity, like this one, provides a fun and engaging way to learn this essential technique. By creating their own microliter masterpieces, […]
The Polymerase Chain Reaction (PCR) is one of the most important tools in the molecular biology lab. miniPCR bio makes equipment labs and teaching resources to make bringing this essential technique into your classroom easy. Watch this brief video by Dr. Alex Dainis to see how we make it easy to get started with PCR […]
Gel electrophoresis is a foundational biotech skill. miniPCR bio has resources to help bring this technology to your classroom as a tool to teach genetics, human health, and more. In the short video below, Dr. Alex Dainis shares our main resources for teaching gel electrophoresis in your classroom: We have three gel electrophoresis systems designed […]
The eDNA Collaborative has identified twenty-two inspiring researchers whose projects exemplify the power of eDNA science. These diverse researchers hail from all corners of the globe and their research addresses environmental management and conservation challenges using molecular methods. The Microgrants Program supports eDNA researchers with materials, equipment, and educational learning, providing funding to traditionally under-funded […]
Join Dr. Kristin Hennessy-McDonald on February 12, at 3 PM EST as she introduces the True Blue™ Transformation Lab: Genetically Engineering Bacteria. This 45-minute webinar will explain how teachers can effectively integrate our innovative bacterial transformation lab into their curriculum with a protocol that can be tailored to diverse classroom schedules. True Blue™ Lab features: […]
The eDNA Collaborative has identified twenty-two inspiring researchers whose projects exemplify the power of eDNA science. These diverse researchers hail from all corners of the globe and their research addresses environmental management and conservation challenges using molecular methods. The Microgrants Program supports eDNA researchers with materials, equipment, and educational learning, providing funding to traditionally under-funded […]
Ah, the micropipette. This little marvel of engineering allows us to transfer minuscule volumes of liquid with unparalleled precision. Whether you’re a new science enthusiast or an educator guiding fledgling scientists, the art of pipetting can inspire both awe and, often, a little anxiety. This blog post is your gateway to conquering the pipette, weaving […]
Have you ever stumbled upon beautiful fungi in the woods and wondered, “What is that?” Well, thanks to fungal DNA barcoding, the answer is just a PCR test away! DNA barcoding is revolutionizing the way we identify and classify fungal species, offering a powerful tool for researchers, citizen scientists, and amateur mycologists. In this blog […]
At miniPCR bio, we believe that groundbreaking science shouldn’t be confined by borders or budgets. That’s why we’re thrilled to partner with The eDNA Collaborative on their Microgrant Program, an initiative designed to ignite environmenral DNA discovery across the globe. This year, in collaboration with miniPCR bio, The eDNA Collaborative has identified a diverse and […]
In this blog post, we’ll break down the basics of what primer dimers are, how they form, how to interpret them, and how to minimize their impact on your PCR results. We will be referring mainly to conventional PCR results; for a specialized discussion of primer dimers in quantitative PCR (qPCR), read this article or […]
A remarkable journey of a decade calls for a celebration, and at miniPCR bio, we’re thrilled to mark our 10th anniversary with a bang! Since our inception, we’ve been dedicated to empowering scientists, educators, and curious minds with cutting-edge tools for molecular biology. Today, we are excited to announce the launch of our special 10th-anniversary […]
Loading DNA or RNA samples for gel electrophoresis takes a little practice. Our video breaks it down for you: Need more guidance? Share these simple tips with your students to have them pipetting like the pros in no time: 1. Brace yourself — you are aiming for a small target. Rest your elbows on your […]
If you are looking to perform a lab using bacteria, you must first pour Luria-Bertani (LB) agar plates. LB agar is a nutrient-rich media that typically serves as growth media for bacterial cells. Here, we share some tips and tricks for pouring LB agar plates for your lab or classroom. Note: These instructions are for […]
If you are someone who loves science (and if you have found this post, then you probably are), then you want to make it as engaging for your students as it is for you. What better way to do this than to activate your students’ senses with movement, imagery, and sounds? Multimodal learning suggests that when a […]
Our minipettes are fixed-volume micropipettes that offer the look and feel of “the real thing” while reducing the margin for error that comes with dialing in volumes. Students can build confidence as they practice with minipettes, and carry their skills over to variable micropipettes when they are ready. And at $11 a piece, the price […]
Scientists use bacterial transformation in a wide variety of laboratory, agricultural, pharmaceutical, and medical applications, from the creation of medical-grade insulin to enzymes used in detergents. Now, with the True Blue™ Transformation Lab, you can seamlessly introduce this powerful bioengineering technique to your biology class. In just 45 minutes, students can embark on an exciting […]
We are proud to announce the launch of a free digital resource for teachers and students: Microbe Hunters Digital. This virtual lab invites students to address a space biology challenge: Can they determine whether dangerous bacteria have stowed away aboard the International Space Station before any crewmembers are sickened? Along the way, students learn about […]
Beer fermentation is one of the oldest biotechnologies. There are many strains of yeast used in brewing, and the type of yeast used can affect the beer’s smell, taste, and appearance. Breweries can buy yeast commercially or raise their own, but either way, it is essential to make sure you are using the type of […]
What is a DNA transilluminator? Transilluminators are used in molecular biology laboratories to view DNA or RNA that has been separated by agarose gel electrophoresis. Exposing the stained gel to a light source makes the DNA fluoresce and become visible. If you’re considering getting a new transilluminator to visualize DNA or RNA, you’re facing a […]
Project-Based Learning (PBL) asks students to gather critical knowledge through the process of performing a long-term project focused on answering a complex, real-world question. These projects integrate many of the Science and Engineering Practices, including Asking Questions and Defining Problems, Planning and Carrying Out Investigations, and Analyzing and Interpreting Data. Integrating Project-Based Learning with miniPCR […]
Professor Linda Nicholas-Figueroa of Iḷisaġvik College in Utqiaġvik, Alaska has been traveling to North Slope villages to hold free biotech workshops in remote rural communities. Using miniPCR equipment, she’s able to introduce kids in Alaskan villages to basic molecular biology techniques. Alaska’s only tribal college, Iḷisaġvik is located in Utqiaġvik, Alaska, the northernmost community in […]
The first step in any type of genetic testing is to collect a DNA sample. miniPCR offers robust lab kits to explore the connection between genotype and phenotype using yourself as an experimental subject, including the ability to taste PTC and morning vs. evening preference. Our easy-to-use miniPCR DNA extraction buffers, included in those lab […]
We are proud to introduce Learning Lab™ E-worksheets™: a new addition to the miniPCR bio Learning Labs you love. Learning Lab E-worksheets were designed with the goal of helping teachers to align student Learning Lab assessment questions with their specific classroom needs. Learning Lab E-worksheets are editable Google Docs that make it easy to […]
Add a layer of hands-on inquiry to your genetics lessons with the Mendel’s Peas Dye Electrophoresis Learning Lab! Designed with middle school and introductory biology students in mind, Mendel’s Peas allows students to take on the role of plant geneticist, as they connect phenotype to genotype in a case study grounded in biotechnology research. In […]
On Monday, September 11 at 3PM ET, join miniPCR bio curriculum specialist Dr. Kristin Hennessy-McDonald as she introduces our latest dye electrophoresis Learning Lab, Mendel’s Peas. This webinar will explore how students can take on the role of plant geneticists and use electrophoresis to aid in connecting traditional Mendelian genetics with our modern understanding of […]
If you know miniPCR, you might already be familiar with BioBits®: the cell-free protein expression system you can use to make core biology topics come to life. Because students simply need to add water to express a variety of proteins, the system is ideal for educational uses ranging from the demonstration of fundamental cellular processes to […]
SEATTLE, Aug. 3, 2023 — Isabel Jiang, 17, is this year’s winner of Genes in Space, a biology-based research competition co-founded by Boeing’s Space Exploration division and miniPCR bio. The announcement was made at the International Space Station (ISS) Research and Development Conference in Seattle. Jiang’s experiment will be performed by astronauts aboard the space station next […]
Everyone’s favorite portable thermal cycler, the miniPCR®, allows you to program and run your PCR experiment on your own device. Whether you are using a Windows, Mac, Android, Amazon Fire, iOS, Chromebook, or Linux device, this guide will walk you through how to connect your miniPCR to your device. Note: this guide only applies to […]
Everyone’s favorite portable thermal cycler, the miniPCR® comes in two sizes: the mini8X and the mini16X. Not sure which miniPCR to get? This guide will walk you through the differences between the two and help you choose the miniPCR that best fits your needs! Note: this guide only applies to the new mini8X and mini16X […]
Redefining PCR Technology with Compact and Accessible Design Cambridge, Mass., August 1, 2023 – Today, miniPCR bio, a leading provider of molecular biology solutions, proudly announces the release of their latest innovation: the revamped miniPCR thermal cyclers. Building upon the success of the classic miniPCR, this revamped machine retains its compact size, energy efficiency, and […]
We are thrilled and honored to celebrate a significant milestone in our journey today—the tenth anniversary of miniPCR bio! It feels like just yesterday when our team embarked on a mission to make science accessible where it wasn’t possible before. Looking back on the incredible progress we’ve made, we are filled with gratitude. When we […]
One week before her high school graduation, Pristine Onuoha will travel to Cape Canaveral, FL to send some precious cargo up to the astronauts aboard the International Space Station (ISS). As winner of the 2022 Genes in Space contest, she is the mastermind behind Genes in Space-10, a novel space biology investigation scheduled to launch […]
Led by teacher Jon Hale on the Island of Jersey (UK), the Daffodil DNA Project brings together scientists from universities and research institutes with schools to sequence the chloroplast genomes of different varieties (cultivars) of daffodils. The scientific goal of this project is to obtain genetic data on this very understudied, yet valuable genus. To […]
Next-Level DNA and RNA separation made easy Introducing GELATO™ electrophoresis and visualization system Welcome to the world of molecular separation! If you’re a scientist or researcher, you know how crucial gel electrophoresis is for analyzing DNA and RNA. But have you heard about the game-changing GELATO electrophoresis system? Let’s dive in and explore how this […]
Join Dr. Ally Huang on YouTube Monday, May 22 at 3pm EDT for a demo of our all-new BioBits®: Antibiotic Resistance Lab. Learn how you can engage your students in testing antibiotics and a resistance gene — without culturing bacteria. A recording of the session will be available to view after the live stream concludes. […]
…and how to use a DNA gel setup to run proteins Analyzing DNA with agarose gel electrophoresis is becoming increasingly common in classrooms thanks to affordable, easy-to-use equipment (such as the blueGel™ electrophoresis system). But DNA isn’t the only biomolecule you can run on a gel. Scientists often analyze proteins using gel electrophoresis as well. […]
Explore the mechanisms of antibiotic resistance The spread of antibiotic resistance is one of the great public health challenges of our times. Explore the mechanisms of antibiotic resistance with an easy-to-implement hands-on lab. Our BioBits® cell-free model lets you study antibiotic resistance without growing bacteria! A molecular level antibiotic resistance lab easy to implement in the […]
Visualize authentic molecular biology concepts with our easy-to-use BioBits® cell-free system Topics like the Central Dogma and protein structure and function are critical for biology students to grasp, but difficult to teach in a hands-on way. That’s where our BioBits® cell-free system comes in. BioBits is a cell-free protein expression system you can use to […]
Some gel electrophoresis systems allow you to set the voltage for your gel run. Here, we will discuss how to select the voltage for your classroom gel electrophoresis experiment. Selecting the gel electrophoresis voltage A general recommendation is to use 5-10 V for every centimeter of distance between the electrodes in your gel system: Voltage […]
The widespread availability of affordable biotechnology has led to a revolution in citizen science for molecular biology. You can contribute to projects tracking antibiotic resistance in environmental samples, identify the mushrooms growing in your own backyard — or even use DNA to get a better understanding of your pets! Meet Dr. Hannah Seidel, Associate Professor […]
Electrophoresis experiments sometimes list a specific percentage of agarose to use in the gel. Let’s dive into where these recommendations come from so you can pick the right concentration of agarose for your gel electrophoresis experiment. What does agarose gel percentage mean? Scientists typically use agarose gels between 0.5% and 2%. Agarose gels are made […]
This blog post is the last of 4-part series on PCR primers. Elsewhere on our blog, you can find posts on understanding PCR primers, designing quality primers, and ordering primers. So, you’ve just ordered new primers. How do you prepare them for use in a PCR experiment? Primers (or “oligos” for “oligonucleotides”) are typically mailed […]
Looking for an authentic lab to teach genetics or human health? PCR is an important biotech skill that can demonstrate many of these biology concepts and applications in the classroom. This guide will show you how to bring PCR to your classroom! What is PCR? Nearly every experiment or test in a modern biology lab […]
Looking for an authentic lab activity to teach your students about genetics or human health? Gel electrophoresis is a basic but important biotech skill that can demonstrate a variety of biology concepts. This guide will show you how to bring DNA gel electrophoresis to your classroom! What is gel electrophoresis? One of the most common […]
CRISPR has revolutionized biological research and medicine — and now it’s poised to transform your teaching, too. Harness students’ excitement over this revolutionary technique with our CRISPR classroom materials, including these free resources: Webinars: Whether you’re getting yourself up to speed on CRISPR basics or introducing your students to the technique, our webinars can be […]
Barely-used pipette tips. Untouched gels. Biology experiments can be expensive and also create a lot of waste. Today we will share a few tips for how to get some extra use out of agarose gels. Tip 1: Save unused sections of gels for later use When you cast an agarose gel, you have to make […]
Do you like to cast your electrophoresis gels in advance to save time? In this post, we will walk through basic considerations for storing agarose gels. Store gels in an airtight container Moisture It’s important to keep your gels from drying out during storage. The easiest way to accomplish this is to store agarose gels [...]
Contest offers students a chance to launch a research project to the International Space Station Genes in Space, an annual STEM competition that challenges students to solve big-picture problems faced by space travelers, opened a call for entries today. Each year, the contest invites students in grades 7-12 to design pioneering DNA experiments for the […]
Some of you may be aware that we use a raised fist wrapped in DNA on some of our marketing materials. From worker’s rights movements in the early 20th century to modern-day social justice campaigns, the clenched fist has been adopted by groups across history and geography as a symbol of political strength and solidarity. […]
Looking for hands-on lab activities for beginners? Our new Cat Genetics Learning Lab™ was designed with middle school and introductory biology students in mind! The Cat Genetics Lab includes: Diagrams to explain all background information Boxes with limited text that summarize core concepts Integrated review questions for each section to help students check their understanding […]
Wishing you had something besides paper models or simulations to show how DNA, RNA, and proteins work? With our P51™ Molecular Fluorescence Viewer, you can experiment with those molecules in a simple, visual way. This guide will help you bring this tiny but powerful tool into your classroom. What is fluorescence? Fluorescent molecules absorb light […]
In our new Microbe Hunters Learning Lab™, students use gel electrophoresis to identify microbes growing aboard the International Space Station (ISS), with the ultimate goal of saving astronauts from a dangerous infection. This fictional lab scenario might sound out-of-this-world, but it’s actually based on real-life research taking place aboard the ISS! Meet some of the […]
Elijah Snyder’s hobby is breeding ball pythons. Ball pythons are one of the most popular pet reptiles, and they come in a dizzying array of colors and patterns. Genetic testing of ball pythons – why? Knowing which versions of a gene a snake carries can help breeders generate snakes that have the exact physical characteristics […]
You don’t have to choose between leveling up your biotech curriculum and cutting down your prep time. Our new Microbe Hunters dye electrophoresis Learning Lab™ aims to make your classroom prep easier than ever before. Microbe Hunters introduces Load Ready™ Strips: pre-aliquoted sample strips. With Load Ready Strips, samples are already divided into portions suitable […]
Clinical Laboratory Technician, Biofuel Engineer, Molecular Biology Technician, Quality Control Chemist—even Brewmaster. What do all of these jobs have in common? They are all require skills in biotechnology! The need for individuals trained in biotechnology techniques continues to grow. The field of biotechnology technicians is expected to grow by almost 10% over the next ten […]
Bring the essentials of biotechnology to your classroom. Now with the Bandit™ Biotech Bundle you’ll have everything you need to open the door to the world of biotech to introductory classrooms, on an introductory budget. Your students will be able to: Develop pipetting skills and engage your creative side with micropipette art. Build a functional […]
The Bandit™ STEM Electrophoresis Kit is a low-cost, high-fun kit you can use to introduce students to biotechnology. How does it work? With Bandit, we break electrophoresis down into a few simple steps: Cast your gel: Turn prep into pedagogy when you make gel casting part of your experiment. Use our From Circuits to Molecules […]
Buying your first set of classroom micropipettes or teaching students how to micropipette for the first time? Don’t worry – we’re here to help your classroom build basic micropipetting skills. What are micropipettes? Micropipettes allow scientists to precisely measure small volumes, and are essential tools in the molecular biology lab. Nearly every single classroom […]
Looking for how miniPCR bio Learning Labs align to the AP biology frameworks? Check out our full list of AP Biology-aligned Learning Labs from miniPCR bio™ Visit our AP Bio product selection tool Biotechnology may be listed as topic 6.8 in the AP Biology Course and Exam Description, but really, biotechnology is not a standalone [...]
Guest post by Dr. Leopoldo Naranjo, CSO at Spora Biotech As part of the charge to save our planet Earth and the living species that inhabit it, it is crucial to reinvent the high-mass consumption products that savagely pollute our planet-home. As mindful citizens of the world, we must respond to the enormous mistakes of […]
This blog post is the third in 4-part series on PCR primers. Elsewhere on our blog, you can find posts on understanding PCR primers, designing quality primers, and storing and using primers. PCR primers are a central ingredient in any PCR and a key component to all of our PCR-based Learning Labs. When designing a […]
Student-designed project will investigate basis of telomere lengthening in astronauts Washington, D.C., July 28, 2022 – Student Pristine Onuoha has won the eighth national Genes in Space STEM competition. Onuoha, who attends East Chapel Hill High School in Chapel Hill, NC, seeks to understand the mechanism behind telomere lengthening, a chromosomal change that has been observed in space […]
Student-designed investigation will test use of biosensors for water quality monitoring July 14, 2022 (KENNEDY SPACE CENTER, Fla.) An experiment by Genes in Space 2021 contest winner Selin Kocalar, 18, of San Jose, California, will launch today to the International Space Station aboard the SpaceX Commercial Resupply mission SpX-25. Kocalar, then a high school senior, won the competition […]
This blog post is the second in 4-part series on PCR primers. Elsewhere on our blog, you can find posts on understanding PCR primers, ordering primers, and storing and using primers. Our PCR-based Learning Labs™ include primers that we have designed and optimized for specific target genes. But users often wonder exactly how we did […]
This blog post is the first in 4-part series on PCR primers. Elsewhere on our blog, find posts on designing PCR primers, ordering primers, and storing and using primers. PCR primers are the key ingredient that makes one PCR different from another. PCR primers are short, single-stranded segments of DNA that are designed to be […]
If you’re looking to run an electrophoresis experiment, you’ll have to begin by pouring an agarose gel. Here, we share three distinct methods of casting gels and help you figure out which is the best fit for your lab or classroom. Three ways to pour an agarose gel 1. All-in-One Agarose Tabs™ contain all the […]
If you’ve ever been stuck on which nucleic acid stain to use in your DNA or RNA electrophoresis experiment, this blog post will help you understand the advantages and disadvantages of using GelGreen® and SeeGreen™, two different fluorescent stains available from miniPCR bio. Fluorescent stains like GelGreen® and SeeGreen™ allow scientists to immediately see their […]
A common point of confusion for students learning DNA gel electrophoresis is understanding the difference between the reagents that aid in visualization. What distinguishes a DNA stain from a loading dye? Let’s talk about the functionality of these two important types of molecules… What is a gel loading dye? A gel loading dye is a […]
CRISPR technology is one of the major bioengineering breakthroughs of the 21st century. You might have heard all about its potential in editing DNA and curing genetic diseases—or even performed it yourself with our Knockout! or Chopped! Learning Labs. But scientists are continuing to improve this technology, and now, there’s even more to learn about […]
Introduce your students to authentic CRISPR/Cas9 The introduction of CRISPR/Cas9 into the biotechnology toolkit has revolutionized the world of genetics. And in just 10 years since CRISPR’s introduction, miniPCR bio is leading the way in bringing CRISPR to the classroom in ways that are both innovative and accessible. miniPCR bio now offers two great options […]
Bring Mendelian genetics and affordable gel electrophoresis to your classroom! With the launch of the Bandit™ STEM Electrophoresis Kit, miniPCR bio™ has renewed our commitment to making high quality, accessible biotechnology equipment that is affordable for any classroom budget. Bandit brings a build-it-to-understand-it approach that allows students to get hands-on with the fundamentals of gel […]
Investigate the mechanisms of CRISPR/Cas9 gene targeting in vitro Take a close-up look at the molecular machinery that makes CRISPR/Cas9 such a powerful genome editing tool! CRISPR/Cas9 gene editing technology has revolutionized the biology world since its introduction in 2012. And in just 10 years since it was developed, CRISPR/Cas is now ready for the […]
Two accessible systems for gel electrophoresis in the classroom by miniPCR bio™ With the introduction of the Bandit™ STEM Electrophoresis Kit from miniPCR bio™, we now offer teachers multiple options for accessible, low-cost classroom electrophoresis. So what system is right for your students? We’ll highlight some of the key differences here. Build it to […]
Want to see our brand-new Bandit™ STEM Electrophoresis Kit in action? Register for our upcoming Bandit™ webinar mini-series. Over the course of three webinars, we will show you how the system can be used to bring electrophoresis into your classroom, and introduce you to dye electrophoresis Learning Labs™ that have been developed especially for use […]
An integrative way to teach gel electrophoresis We’ve got something new for you! Meet the Bandit™ STEM Electrophoresis Kit. Bandit™ is a safe and low-cost STEM activity kit students can use to build and run a working gel electrophoresis system. With Bandit™ electrophoresis, students build it to understand it: by building the system, students will […]
On Monday, April 25 at 3pm ET, join miniPCR bio curriculum director Bruce Bryan to learn more about the P51™ Enzyme Lab: β-Gal Glow™. This webinar will investigate enzyme-catalyzed reactions and will use our unique fluorescent assay to investigate the effect of factors like temperature, concentration, pH, and even competitive inhibitors on the performance of β-Galactosidase. This […]
Use these instructions to assemble your Bandit™ kit. The Bandit™ STEM Electrophoresis Kit allows students to build a working gel electrophoresis apparatus. Then, they use their fully functioning system to run an electrophoresis lab. Learn electrophoresis from the inside out! Note: To complete the following steps, you will need both the Bandit™ STEM Electrophoresis Kit […]
From UK Research and Innovation: Potentially hazardous bacteria in water can be screened rapidly to save lives anywhere in the world thanks to a testing laboratory that fits into a suitcase. The portable testing lab is believed to be the first of its kind. It has been developed by experts from Newcastle University and across […]
On Monday, March 28 at 3pm ET, join Dr. Allison Nishitani on YouTube to learn about using gene therapy to teach students about CRISPR/Cas9 gene editing! This webinar will cover information on the use of CRISPR/Cas to treat genetic conditions, and will include a demonstration of a free paper model activity to teach students about […]
Have you ever wondered about the mushrooms you see growing in the wild? Mycology is the study of fungi, which includes mushrooms. Mushrooms play essential ecological roles and have many useful applications for humans, from food to medicine. There are lots of ways to learn more about mushrooms. Will Padilla-Brown shares his mycology journey in […]
A core topic in biology class is cell communication and signaling, but it is often difficult to engage students on this topic. PTC tasting is a common way to teach simple Mendelian genetics and dominance relationships, but it’s also an excellent example of variation in a cell signaling pathway! In the miniPCR bio PTC Taster […]
Join Dr. Ally Huang for a first look at this upcoming lab. In this session, we will offer a sneak peek at a simple and powerful way to bring real CRISPR/Cas9 to your classroom. In this lab, students will use the CRISPR/Cas9 system in vitro to target and cut DNA in a tube, then visualize their result through an […]
A common example of the link between genotype and phenotype in humans is the ability to taste a particular bitter chemical, called phenylthiocarbamide (PTC). A person’s phenotype (whether or not they can taste PTC) will depend almost entirely on their genotype for the TAS2R38 gene. The TAS2R38 gene encodes a taste receptor protein that detects […]
Linking genotype to phenotype is a fundamental concept in any biology class, and students are always curious to learn more about what in their DNA makes them who they are. However, simple examples of a direct link between genotype and phenotype in humans are hard to come by. That’s why the genetics of bitter taste […]
New users of micropipettes are taught “Always use a new tip!” However, always using a new pipette tip creates a lot of plastic waste. Surely, there must be a better way. Savvy lab practitioners know that a new tip isn’t always necessary. So here we suggest some basic rules for when you definitely need a […]
The spread of antibiotic resistance in bacteria is one of the great public health challenges of our time. We now offer three engaging Learning Labs you can use to teach your students about this pressing issue in an interactive and hands-on way. Which approach is right for you? Agricultural Monitoring Lab: Monitoring Resistant Organisms in […]
At miniPCR bio we believe that the best way to learn science is to do science. For that reason, we work hard to produce activities that provide students with authentic lab experiences with unknown outcomes. With that in mind, we are extremely excited to release our new Learning Lab, eDNA Project: Sampling Soil for Antibiotic […]
Micropipettes allow scientists to precisely measure small volumes, and are essential tools in the molecular biology lab. A single micropipette can cost hundreds of dollars, but luckily, you don’t have to spend that much to get a quality micropipette. miniPCR bio™ offers three types of micropipettes, and this guide will help you decide which micropipette […]
Free webinar for students, teachers, and the general public Join Dr. Alex Dainis for a first look at this new lab.Join Dr. Dainis as she demonstrates the power that molecular techniques bring to the management of infectious disease outbreaks. In this lab, students use PCR and fluorescence detection to test fictional patients for infection with […]
The COVID-19 pandemic has thrust molecular biology techniques in popular discourse like never before, and with that thrust has come a need for quality educational resources. We’ve tried to meet that demand through free resources, webinars and videos, and new hands-on labs. You can check out our entire library of free COVID-19 resources, including educational […]
Q: What is a qPCR test? A: An excellent way to engage your students on topics like viruses, biotechnology, and the interface of genetics and medicine! Quantitative PCR (qPCR) is suddenly on everyone’s radar because it is the gold standard for detection of SARS-CoV-2, the virus that causes COVID-19. For educators this presents an opportunity […]
This spring, join us on YouTube for a continuation of our popular webinar series. We will be highlighting new labs to teach CRISPR/Cas9, the science behind COVID testing, and more. Subscribe to the miniPCR bio YouTube channel to receive updates when we go live. Watch past webinars on YouTube: COVID qPCR Lab Webinar Chopped! Lab […]
Have you ever wondered which DNA stain is best for your gel electrophoresis needs? If so, this blog post is for you! Because DNA is not visible on its own on an agarose gel, scientists use DNA stains to visualize their samples during or after gel electrophoresis. There are many types of DNA stains, each […]
When performing gel electrophoresis, scientists include DNA ladders that contain DNA fragments of known sizes. The ladder enables scientists to estimate the size of the DNA bands in their experimental samples by comparing them to the closest fragment in the ladder. Using the correct ladder will help you estimate your DNA band sizes accurately and […]
Over the last two decades, or longer, you have been bombarded with news about efforts to sequence and understand the human genome. But perhaps you’ve heard a lot less about the quest to decipher the genetic information carried by our canine companions. Most people will agree that dogs are remarkable for many reasons, especially as […]
Student-led project will pioneer a bioengineered method for testing water quality aboard the ISS Cambridge, Mass., July 29, 2021 – Student Selin Kocalar (17) has won the seventh annual Genes in Space STEM competition. Kocalar, who attends Leigh High School in San Jose, CA, proposed to pilot a new technique for detecting waterborne pathogens on the International Space […]
First successful use aboard International Space Station of new technique for studying DNA repair in yeast Researchers have developed and successfully demonstrated a novel method for studying how cells repair damaged DNA in space. Sarah Stahl-Rommel of Genes in Space and colleagues present the new technique in the open-access journal doi.org/10.1371/journal.pone.0253403. This investigation was co-led […]
While applying for grants is a great way to secure funding for your biotechnology program, I also recommend promoting your program to your school community. 1. Use social media to your advantage Athletic and arts programs typically do a great job promoting student accomplishments. I always felt that if the school district can fund extracurricular […]
Building a quality biotechnology program can feel intimidating. Here I will share some advice based on my experience building a successful high school biotechnology program from the ground up. 1. Build your program slowly You don’t have to outfit your lab space all at once! You can gradually add new or used equipment pieces from […]
I first became interested in biotechnology in 2011, but because I graduated from college in 1981, I felt as though I had limited skills and knowledge of biotechnology. Over the years, I learned an incredible amount about biotechnology and built a successful biotech program at my high school from scratch. For me, the key was […]
Guest blog post by Carter Zivin, high school senior in Seattle. “Science and everyday life cannot and should not be separated” – Rosalind Franklin Are you a high school student with an interest in science? Are you driving your parents, friends, and pets crazy with random questions about squid evolution or whatever the latest CRISPR […]
Free webinar for students, teachers, and the general public Join our Curriculum Director on an environmental DNA exploration Join our Curriculum Director, Bruce Bryan, as he takes part in a nationwide monitoring program testing for antibiotic resistance genes in environmental soil samples. We’ll demonstrate how you can select a sampling strategy based on your own […]
Free webinar for students, teachers, and the general public Join Dr. Katy Martin on an exploration of food biotechnology On April 12th at 3 pm EDT, join Join Dr. Katy Martin for a live demo of our popular GMO Detection Lab, which employs PCR and gel electrophoresis to test grocery store foods for evidence of […]
Free webinar for students, teachers, and the general public Oodles of Labradoodles: Join Dr. Allison Nishitani in a new lab exploration! On March 8th at 3 pm EST, join Dr. Allison Nishitani for a first look at miniPCR’s newly released Dog Genetics Lab. We’ll use gel electrophoresis and a litter of Labradoodles to show how […]
miniPCR featured in National Geographic perspective by Fedor Kossakovski “Bombastic biochemist Kary Mullis invented PCR, a tool that redefined genetic science, while driving in 1983. That was only the beginning.,” starts the article published February 19th on the National Geographic website. It goes on to explain the origins of the polymerase chain reaction, how it […]
DNA science meets social justice Over the past several years, forensics classes have become an incredibly popular and important entry point to engage students in scientific practice. But we have noticed that a lot of forensics curriculum takes too narrow a view of how DNA analysis can and should be used. While several labs use […]
Free webinar for students, teachers, and the general public Join Dr. Ally Huang for STEM explorations that GLOW!Join Dr. Ally Huang and learn how to use fluorescence as a powerful tool for hands-on learning. With just our P51™ fluorescence viewer and household items we will reveal the fluorescent world around you, and see common household […]
The development of vaccines against COVID-19 has brought excitement and relief. But it has also raised questions about how mRNA vaccines work. Understanding the science behind mRNA vaccines and why they are different from traditional vaccines requires a grasp of the central dogma of molecular biology, the flow of genetic information from DNA to RNA […]
Students invited to propose experiments using new gene analysis tools aboard the International Space Station Cambridge, MA, January 19th, 2021 – Genes in Space, an annual competition that challenges students to solve sweeping problems faced by space travelers, opened a call for entries today. Each year, the contest invites students in grades 7-12 to design pioneering DNA experiments […]
Free webinar for students, teachers, and the general public Join Dr. Alex Dainis for a live discussion of mRNA COVID-19 vaccines.We’ll cover the science behind mRNA vaccine technology and explain how the information encoded in mRNA confers immunity against SARS-CoV-2. Download webinar slides Student study questions DNAdots: mRNA vaccines
Free 1-hour webinar open to teachers, students, and the public Join Dr. Sebastian Kraves for a deep dive into the genetics of sleep. We’ll learn about the circadian clock and how scientists use genetic association studies to explore links between our DNA and complex traits. Get ready to participate in an authentic investigation! miniPCR Sleep […]
Free 1-hour webinar open to teachers and students Join Dr. Allison Nishitani for a first look at miniPCR’s upcoming CRISPR/Cas lab. Learn how scientists use CRISPR/Cas to disable genes in living cells and watch Allison demo Knockout! A CRISPR/Cas gene targeting lab. Free CRISPR/Cas activities and resources will be included. Webinar slides Knockout! Lab webinar […]
When the COVID-19 pandemic set in and classes went virtual, Marianne Lindahl-Allen, PhD and Uzo Erlingsson, M.D knew they had to think outside the box. Before the pandemic, they had worked together to adapt a Harvard Medical School lab curriculum into an immersive laboratory medicine course for high school students. Their curriculum presented clinical care […]
Join us on a conservation genetics trip to Madagascar! On Oct 26th at 3pm EDT, join miniPCR bio™ and the Duke Lemur Center as we travel to Madagascar to study the elusive dwarf lemurs. We’ll demo our new lab and use authentic field data to explore how modern genetic techniques have opened up new understandings […]
The unique partnership, funded in part by the Massachusetts Life Science Center, provides hands-on biology labs developed by miniPCR bio. Oct. 7, 2020 –Boston–Two hundred twenty-five individual lab kits are being delivered to high schools across Boston as part of Mass Insight Education & Research (Mi) Advanced Placement (AP) STEM & English program. Partnering with […]
Dr. Ally Huang previews a brand new lab using the BioBits® cell-free system In this live session, Dr. Ally Huang demonstrates how the BioBits® cell free system can be used to illuminate protein structure and function relationships. Using fluorescent proteins, we engage on the basics and the practice of protein engineering. If you’re interested in […]
Free webinar for students, teachers, and the general public Join miniPCR bio and Dr. Alex Dainis for a discussion of COVID-19 vaccines! We’ll cover the history of vaccines, the science of how they help your immune system fight infection, and the new methods that scientists are using to create a vaccine against SARS-CoV-2. Download webinar […]
New laboratory tool promises analytical power in a small footprint CAMBRIDGE, Mass., Sept. 8, 2020 /PRNewswire/ — miniPCR bio, a manufacturer of scientific tools for educators and researchers, today announced the launch of the GELATO™, an integrated DNA analysis system. GELATO™ combines gel electrophoresis with transillumination technology, allowing for simultaneous nucleic acid separation and visualization in a single, […]
Student-led investigation will focus on spaceflight-induced changes in drug metabolism Boston, MA, August 6, 2020 – Student Kristoff Misquitta (17) has won the sixth annual Genes in Space competition. Misquitta, who attends Stuyvesant High School in New York, NY, proposed to study drug metabolism on the International Space Station (ISS). His experiment will be performed by astronauts aboard the ISS next year. […]
With all the uncertainty surrounding the upcoming school year regarding COVID-19 and its impact on what classrooms will look like in the fall, we’ve decided to round up all our resources that might help support biology teachers with new teaching models. Whether that’s teaching remotely or a hybrid model, hands-on activities and labs will be […]
Boston, July 23rd 2020. miniPCR bio™ announced today its plans to distribute its line of molecular biology products in the Indian market in partnership with Biolinx India Pvt Ltd. To scale up their presence in the Indian market, the companies hosted a virtual launch event on 23rd of July 2020, organized by Biolinx India Pvt Ltd., and presented by Sebastian […]
Join Dr. Katy Martin for a first look at our upcoming Viral Diagnostics Lab, scheduled for release this fall. Students learn how molecular techniques can identify the viral agents causing infectious disease outbreaks, and watch Katy use gel electrophoresis to test fictional patient samples in real time. Appropriate for introductory through advanced biology students, this lab […]
Join Dr. Allison Nishitani for a live webinar on forensic DNA analysis. Learn how forensic scientists create DNA profiles and watch Allison test DNA evidence using gel electrophoresis. This webinar is ideal for distance learning. Students can use Allison’s data to gain experience analyzing real gel electrophoresis results. Free worksheets will be available to guide […]
In light of the 2020 COVID-19 pandemic, schools had to shift their teaching from the classroom to online. This limited teaching to mostly sharing virtual resources, such as slides, videos, and worksheets. However, for the sciences, there is no replacement for authentic, hands-on lab activities or experiments that engage students and allow them to apply […]
Join us for a free lab demo. Dr. Ally Huang performs a live demonstration of two engaging labs that require just a micropipette and a simple fluorescence viewer. The P51™ DNA Glow Lab™ explores DNA structure hands-on, observing how sequence, temperature, and other variables influence base pairing. The P51™ β-Gal Enzyme Glow Lab reveals enzyme […]
Join our curriculum director, Bruce Bryan, for a live demo of one of our most popular labs. Using gel electrophoresis, we will explore the links between genes and disease by diagnosing a fictional family for sickle cell anemia. See how a simple lab exercise can lead students through a rich exploration of a wide array of […]
Join Dr. Katy Martin for a live demonstration of the Genes in Space Food Safety Lab, which shows how molecular methods can be used to track and control disease outbreaks – on Earth and in space. Teachers will also learn how they can apply for a free loan of the Food Safety Lab kit to […]
Many students around the world are experiencing online learning for the first time as part of the efforts to slow the spread of COVID-19. Yet distance education had been growing in popularity even before the pandemic. Online education makes college training accessible by offering more flexibility at a lower cost than a traditional degree. While […]
Join Alex as she walks through miniPCR bio’s qPCR Learning Lab, explaining how fluorescence can help us to diagnose disease. Learn about how this technique combines the amplification of PCR with the power of fluorescence to make DNA replication visible and measure gene expression or viral load. Related resources: Webinar slides Student questions COVID […]
Back in September 2019, I helped miniPCR bio launch the very first official BioBits® lab. Over the next six months, I got to see something I co-developed in grad school turn into an actual classroom tool that real teachers and students were using and learning from. BioBits® was started as a collaboration between the Jim […]
A live CRISPR webinar with Dr. Emily Gleason On April 27th Dr. Emily Gleason took us on a journey through the history of this powerful genome editing tool, its biomedical applications, and how it can be used by high school students. Get the science behind the gene editing tool that has transformed our world. Appropriate for all […]
PTC Taster Lab – Live demo of PCR, restriction digest and gel electrophoresis On April 20th at 3 pm EDT, our curriculum director, Bruce Bryan, performed a live demo of one of our most popular labs. Using the biotechnology tools of PCR and gel electrophoresis, Bruce will link his ability to taste bitter flavors (phenotype) […]
Webinars with BioBits co-developers Jessica Stark and Ally Huang Join Dr. Ally Huang and Dr. Jessica Stark for an overview of the cell-free technology behind BioBits and how it is used in on-demand diagnostics, medicines, and vaccines. Then watch Ally perform a live demo of the BioBits Central Dogma Lab! No science background required! Watch this webinar series: […]
Watch our free webinar for students, teachers, and the general public In this webinar, Dr. Alex Dainis shared up-to-date reliable information on the science behind the pandemic and efforts to contain it through molecular testing. During the live stream, we answered attendee's questions about the genetics of the novel coronavirus SARS-CoV-2, which causes COVID-19. Watch recording on YouTube Associated [...]
I am passionate about mushrooms and like most other fungi lovers, I came to mycology (the study of fungi) through the kitchen door. Finding wild edibles in my local park led me to join my local mushroom club, the New York Mycological Society. But this passion soon turned into a much broader interest in the […]
New Genes in Space research has recently been published in the journal FASEB BioAdvances. The paper details results from the experiment designed by then high school students Julian Rubinfien, winner of the 2016 Genes in Space U.S. competition, with guidance from his mentor, MIT scientist Dr. Deniz Atabay, and other members of the Genes in Space […]
2019 Genes in Space winners Finsam Samson and Yujie Wang descended on Houston this week to take part in Space Biology Camp. At Space Biology Camp, Genes in Space winners carry out their winning experiment on the ground to help troubleshoot the procedure ahead of its launch to the International Space Station (ISS). The team […]
miniPCR bio is proud to announce together with BioBuilder® and Carolina Biological Supply the release of a new lab for aspiring synthetic biologists and their teachers. The BioBuilder® Golden Bread PCR kit offers a chance to study the molecular underpinnings of a unique phenotype displayed by Golden Yeast. Synthetic biologists have engineered Golden Yeast to […]
This week, Genes in Space shipped the first Lab in a Box biotechnology equipment loan of the 2019-20 school year! This is the first of 27 loans that are scheduled to ship this year. Through Lab in a Box, teachers across 18 states will be able to bring DNA technology into their classrooms, giving many of their […]
From Bruce Bryan, Curriculum Director at miniPCR bio. Students learn best when information is presented to them in a variety of formats. As teachers, we can be very good at giving students information in visual and auditory forms but, in the sciences especially, it can be difficult to present students with authentic kinesthetic learning activities. […]
Cutting-edge technology for making proteins in a test tube now available to educators September 12, 2019, Cambridge, MA – Today, miniPCR bio™ launched BioBits™, an advanced synthetic biology system that can perform biological experiments without the need for living cells or specialized equipment. The BioBits™ system enables protein synthesis at very low cost, making it ideal […]
This guest post was contributed by team member Ally Huang. While I had always enjoyed learning about biology in high school, it wasn’t until I started working in my first molecular biology lab in college that I really fell in love with it. Something about being able to actually hold all those seemingly abstract biological reactions that I learned about from […]
Guest post by Lab in a Box recipient Jennifer Allsbrook My name is Jennifer Allsbrook and I have been teaching secondary science since 1993. I teach college-level Biology 111 and 112, Chemistry, and Introduction to Biotechnology at Polk County High School in Columbus, North Carolina. Students enrolled in these classes range from 10th to 12th grade. I created a […]
In fall 2017, Genes in Space established the Lab in a Box biotechnology equipment loan program. This free program offers educators a chance to put DNA analysis tools in their students’ hands, allowing them to experiment with essential molecular biology techniques like polymerase chain reaction (PCR) and gel electrophoresis. We are proud to have wrapped […]
At miniPCR bio, our goal is to make equipment and activities that genuinely improve student learning while remaining affordable. Still, we realize the state of school funding, and understand that any purchase of lab equipment can represent a sizable investment that can stretch or even surpass many classroom budgets. Grant funding can be an excellent […]
BioBits™ Health is an educational kit for teaching antibiotic resistance and CRISPR-Cas9 gene editing in classrooms, made possible by the development of user-friendly lab activities based on freeze-dried, cell-free reactions and supporting curricula. BioBits™ applications are now being developed at miniPCR Bio, and will soon be available at the miniPCR store! Learn more about BioBits™. Artwork by […]
Student-led experiment edits yeast genes to study DNA repair in space May 23, 2019, Cambridge, MA – For the first time, astronauts have used CRISPR/Cas9 technology to edit DNA in space. The gene editing technique was deployed on the International Space Station (ISS) to induce targeted breaks in the yeast genome. Molecular changes left behind as yeast […]
PLoS One. 2019 May 9;14(5):e0215642. doi: 10.1371/journal.pone.0215642. eCollection 2019. González-González E1,2, Mendoza-Ramos JL1,2, Pedroza SC1,3, Cuellar-Monterrubio AA1,3, Márquez-Ipiña AR1,2, Lira-Serhan D3, Trujillo-de Santiago G1,3, Alvarez MM1,2. Author information Abstract The development of point-of-care (POC) diagnostic systems has received well-deserved attention in recent years in the scientific literature, and many experimental systems show great promise in real settings. However, in the case of an epidemic emergency […]
by Melissa Gaskill, NASA. Earth’s atmosphere shields life on the ground from cosmic radiation that can damage DNA. Astronauts in space have no such protection, and that puts them at risk. An investigation on the International Space Station examines DNA damage and repair in space in order to help protect the long-term health of space travelers. An organism […]
Research could help protect astronauts from radiation damage on long missions to deep space KENNEDY SPACE CENTER, Fla. (May 3, 2019) – The winners of the 2018 Genes in Space competition, Aarthi Vijayakumar, 17, Michelle Sung, 17, Rebecca Li, 17, and David Li, 18, of Minnesota, will see their DNA experiment launch to the International Space Station (ISS) […]
Add some fluorescent spice to your old leaf chromatography lab. If you teach or learn biology, you have likely performed some version of leaf chromatography. In its best form, leaf chromatography can clearly separate the distinct pigments that give leaves their color. In its more common classroom variation, leaf chromatography shows a smudge of green […]
P51™ Glow enzyme lab lights up NGSS and AP Biology Standards. If you are at all familiar with AP Biology curriculum, Next Generation Science Standards (NGSS), or just science teaching best practices, you know that inquiry is the way to go. Students learn material best when they struggle to reach answers, and in the process, […]
Wisconsin Fast Plants® have been a staple of Biology classrooms for decades. With short generation times, high productivity, and many distinct visual phenotypes, generations of students have used Fast Plants® to study a variety of topics ranging from Mendelian genetics, to artificial selection, to energy flow through ecosystems. But as molecular techniques such as PCR […]
Genes in Space research has been published, again! The experiment designed by Alia Almansoori, winner of the first international Genes in Space Contest, was published today in the peer-reviewed journal PLOS ONE. Harvard scientist Dr. Tessa Montague and the Genes in Space team mentored Alia through the design, execution, and interpretation of her experiment. In addition to watching […]
“I love the simplicity of minPCR…after all, if astronauts can do this, anyone can!! Astronauts are not typically molecular biologists. Right?” — Brenda Bott. Coordinator/Teacher. Shawnee Mission School District Biotechnology Signature Program. Center for Academic Achievement. Indeed, Brenda! Astronauts are multi-talented jacks of all trades, but rarely are they masters of molecular biology — notable exceptions include US astronauts Dr. Peggy […]
PCR comparative analysis of P. falciparum polymorphic marker MSP 2 using miniPCRTM, Eppendorf Lightcycler and MJ Thermocycler 1,2Oguzie Judith, 1,2Ajogbasile Fehintola, 1,2Uwanibe Jessica, 1Eromon Philomena, 1,2Onikepe Folarin, 1,2Christian Happi*. 1African Center of Excellence for Genomics of Infectious Diseases, 2Department of Biological Sciences, Redeemer’s University, Ede, Osun State, Nigeria Plasmodium falciparum, the most dangerous malaria parasite […]
— Guest post by Bertina Telusma, MIT Biology Department. A purpose-led life is a blessed life. This model has shaped my adolescent years onward. Early on in my life, I gained the awareness that life fulfilment depended on contributing to something larger than oneself. This sentiment is mostly rooted from my childhood experiences living in the […]
Dr. Reut Sorek-Abramovich, an astrobiologist and research fellow at the The Dead-Sea and Arava Science Center (DSASC), Israel, has presented students from the International Space University (ISU) participating in SSP18 in Delft, the Netherlands, with a specific tailored astrobiology workshop. The workshop was designed to give the participants hands on experience with DNA extraction and […]
— Guest post by Mike Stiff, Ph.D., and undergraduate student Hannah Aaron. A Sweet Research Interest Undergraduate researcher Hannah Aaron is fascinated by honey. Her interest began when her family looked into keeping bees when she was a student at Lenoir-Rhyne University in Hickory, NC. She learned about many uses for the delicious sweetener, including […]
At the University of Innsbruck in Austria, undergraduate biology students are gaining hands-on molecular field experience in the Alps. Professor Birgit Schlick-Steiner, head of the Molecular Ecology research group, leads 120 students every summer in a practical application of molecular ecology, part of a four-day program training the students in eight different areas of biology. Professor […]
This week, as part of an intensive training for high school Biotechnology teachers from the Ort schools in Israel, participants received an in-depth look into the DNA world that we live in from Gita Reinitz, the miniPCR representative in the Middle East. Teachers learned about the importance of DNA in our everyday lives, from genetically […]
– by Bruce Bryan miniPCR curriculum director. This past September, I joined miniPCR as the new Director of Curriculum, working to develop labs and other materials for teachers to use in the classroom. Joining the miniPCR team, however, meant leaving my classroom of nine years, where I taught all levels of high school biology including […]
The Diversity in STEM Award was instituted by miniPCR to celebrate champions of diversity in STEM education. Earlier this spring, we announced the first awardee, Mr. Gavin Smith. Today we’re proud to announce three additional Diversity in STEM awardees. Each one will receive $1,500 in miniPCR store credit. We were moved and inspired by all […]
Since the launch of the DNA Discovery System™ backed by a Kickstarter campaign in 2014, we’ve been working to bring science to everyone, everywhere. The blueGel™ integrated electrophoresis and visualization system has now been used in thousands of research labs and biotech teaching classrooms around the globe to separate and visualize DNA safely and efficiently. […]
This article by the International Space Station Program Science Office first appeared on April 24th, 2018, in NASA Mission Pages. April 24, 2018 – What do astronauts, microbes, and plants all have in common? Each relies on deoxyribonucleic acid (DNA) – essentially a computer code for living things – to grow and thrive.Studying DNA in space could […]
Research could lead to DNA-based methods to monitor astronaut health KENNEDY SPACE CENTER, FL. (April 2, 2018) – The winners of the 2017 Genes in Space competition, Sophia Chen, 15, of Washington and Elizabeth Reizis, 15, of New York, will see their DNA experiments launch to the International Space Station (ISS) on April 2, aboard NASA’s Commercial Resupply […]
The Diversity in STEM Award was recently announced by miniPCR to celebrate champions of diversity in STEM education. Today we’re proud to announce the first Diversity in STEM awardee: Mr. Gavin Smith, science teacher at the John D. O’Bryant School of Math and Science in Roxbury, Massachusetts. Mr. Smith strives to provide students with the necessary […]
Recognizing teachers, mentors, or scientists who are champions of diversity in STEM education We are honored to announce the Diversity in STEM Award to celebrate individuals who work to increase the interest and engagement of minorities underrepresented in the science, technology, and engineering workforce. The miniPCR Diversity in STEM Award provides $1,500 in miniPCR store credit*. This award […]
When students in Camille Merck’s AP biology class at Stafford High School in Texas participated in Lab in a Box, the free biotech loaner program supported by Genes in Space partners, Houston Community College Southwest Stafford TV Studio featured Merck and her students in one of their Spartan Spotlight segments. We are excited to share this […]
Genes in Space workshop in Southern California miniPCR curriculum director, Bruce Bryan, traveled to Southern California to train teachers in the use of miniPCR equipment and to spread the word about the Genes in Space program. As a bonus he, and the miniPCR, got to co-pilot a glider. It wasn’t the highest miniPCR has flown, but it […]
DMU students work with local communities on the island A group of science students from De Montfort University Leicester (DMU), United Kingdom, have taken part of a recent visit to Bermuda to work on promoting science with the community during a #DMUglobal trip to the island. 18 Biomedical Science, Medical Science and Forensic Science students spent a week in Bermuda […]
Being able to identify microbes in real time aboard the International Space Station, without having to send them back to Earth for identification first, would be revolutionary for the world of microbiology and space exploration, and the Genes in Space-3 team turned that possibility into a reality this year when it completed the first-ever sample-to-sequence […]
Aloha from Hawaii. Johanna Anton shared miniPCR with intro Biology students at Hawai’i Community College – Pālamanui campus, which is the only community college on the West Side of Hawaii Island. This was the first ever PCR lab at Palamanui! Students did the Missy Baker Missing Learning Lab using miniPCR and the blueGel system. […]
miniPCR is proud to announce that 2015 Genes in Space winner Anna-Sophia Boguraev’s experiment has been published today in the Nature Publishing Group peer-reviewed journal NPJ Microgravity. The team led by Anna-Sophia showed for the first time that target DNA sequences can be successfully amplified in microgravity under a variety of conditions. The pivotal experiments […]
The Texas Association of Biology Teachers (TABT) held its Annual Luncheon in Houston, Texas, in the context of the 2017 Conference for the Advancement of Science Teachers (CAST). This was a very successful event at what is a pivotal conference for science teachers across the state. Much of that success is due to the overwhelming […]
Robust PCR performance in 24 minutes Being able to do high-speed PCR, especially in time constrained settings such as STEM education environments, is a key step to make molecular biology accessible and practicable. Below we share how the miniPCR™ machine can be used to deliver robust and reproducible PCR results in 24 minutes or less. Polymerase […]
The miniPCR team is always working to make science simpler and more accessible. Today we’re excited to announce the full release of the miniPCR app for Chrome OS. We started this development with classrooms in mind. Chromebooks are taking classrooms by storm: Google recently announced that there are now over 20 million teachers and students […]
— This case study was written in collaboration with James Bevington, Commander of Mission V at HI-SEAS, a NASA-funded 8-month Mars analog isolation mission that began in January and recently ended on September 17th, 2017. The crew of six shared a geodesic dome atop Mauna Loa in Hawaii as a research study designed to better understand the […]
— This case study contributed by Aaron Pomerantz and Stefan Prost from the Ecuadorian rain forest appeared originally on 7/19/2017 in thenextgenscientist.com. It illustrates that in times when we are losing the natural world faster than ever, using new tools can make biology and conservation more efficient. Rapid DNA sequencing in the field can be a […]
The need for speed…to save the pigs Dr. Angelito Abaoag’s microbial technology company, Microbiome Pte. Ltd., Singapore, develops microbial-based solutions for agriculture, livestock, and waste management. The company works with farmers from countries all over Southeast Asia, especially in Dr. Abaoag’s home country of the Philippines, to prevent the spread of infectious disease in animals. […]
15-year-old Alia Almansoori, who attends Al Mawakeb School Al Barsha in Dubai, United Arab Emirates, was a winner of the Genes in Space UAE student scientist competition. “It’s a big thing to dream about… I’m only 15 & I’m sending my experiment to space, so … there’s no impossible!” Learn more about the Genes in […]
Genes in Space Names Two Winners in Unprecedented Tie DNA analysis experiments to be performed aboard International Space Station Washington, D.C., July 20th, 2017 – Genes in SpaceTM named two winners of its third US competition. In an unprecedented tie, Sophia Chen from Washington and Elizabeth Reizis from New York will both have their experiments performed aboard the International […]
The crisis in Science, Technology, Engineering and Math (STEM) education extends outside of the United States and is profound in the developing world. Many countries in Latin America provide young students with very limited opportunities to become engaged with science. In 2014 a group of Harvard graduate students decided to face this problem head-on by […]
— This post contributed by Aaron Pomerantz appeared originally on 7/5/2017 in thenextgenscientist.com I’ve recently been testing portable tools for a project to take the “lab into the field”. One interesting little piece of equipment I heard about was the miniPCR, a portable thermocycler that has been used for field PCR experiments, for instance “A simple, […]
Julian Rubinfien,16, winner of the 2016 Genes in Space competition, watched his DNA experiments launch to the International Space Station from Kennedy Space Center, Fla, on cargo resupply mission OA-7. Watch Julian’s emotions when the rocket launches and hear miniPCR co-founder Sebastian Kraves explain the significance of Julian’s achievement. miniPCR is a proud founding partner […]
From the Lab to the Field (Del Lab al Campo) is a non-profit organization committed to the development and transformation of vulnerable communities in Latin America through science and technology. The team is leading several social impact projects including “Science as a Motor of Dreams”, aimed at improving living conditions of the indigenous Ishipa-Wayúu community in […]
Investigation Aims to Identify Unknown Microbes in Space Adapted from April 25, 2017 NASA article on Genes in Space-3 collaboration. Building on the ability to sequence DNA in space and previous investigations, Genes in Space-3 is a collaboration to prepare, sequence and identify unknown organisms, entirely from space. When NASA astronaut Kate Rubins sequenced DNA aboard the […]
Watch 2016 Genes in Space™ winner, Julian Rubinfien, explain his experiment at NASA’s What’s On Board press conference, with an introduction by miniPCR™ and Genes in Space™ co-founder Sebastian Kraves. Julian’s experiments will enable studies of telomeric DNA sequences on orbit and they were launched to the International Space Station (ISS) on April 18th from Kennedy Space Center, Fla, […]
Research could uncover new information about accelerated aging in space KENNEDY SPACE CENTER, FL. (April 17, 2017) /PRNewswire/ — Julian Rubinfien (16), winner of the Genes in Space competition and a junior at Stuyvesant High School, NY, will launch his DNA experiments to the International Space Station (ISS) on April 18th from Kennedy Space Center, […]
2016 US Genes in Space winner, Julian Rubinfien’s, experiment is headed to Kennedy Space Center. Next stop – space! Zeke Alvarez-Saavedra, miniPCR and Genes in Space co-founder, and Julian’s mentor, Kutay Deniz Atabay, prepared the samples for shipment at the Whitehead Institute in Cambridge, MA. Julian’s experiment will test if telomere-like DNA can be amplified using […]
Myth: PCR always needs to be conducted in ultrapure PCR-grade water Truth: Many PCR experiments produce robust DNA amplification in tap water! After securing lab space and obtaining lab equipment, the next barrier that independent or under-resourced scientists face is the high cost of molecular biology reagents and consumables. This naturally includes plastic ware, enzymes, synthetic DNA oligos, and buffers. Interestingly, there’s […]
Guest post by Vivek Bajaj, PhD, MA, Science Instructor and Director of Professional Development, The Innovation Institute. In our molecular biology and genetics class, we are currently studying the concept of phenotype (the outwardly expressed trait) and how this relates to a genotype (the information in the genetic code as determined by DNA sequence). Nucleotide […]
Students Invited to Design DNA Experiment to be Performed aboard the ISS CAMBRIDGE, Mass., Feb. 8, 2017 /PRNewswire/ — Genes in SpaceTM, a competition that fosters creativity, collaboration and critical thinking among young innovators, opened a call for entries today. The competition challenges U.S. students in grades seven through twelve to design DNA analysis experiments […]
The SXSW 2017 Interactive Innovation Awards celebrate and honor the most exciting tech developments in the connected world. The SXSW panel of judges select only five finalists in each of 13 categories. The miniPCR team is honored to be featured as a 2017 Finalist in the Health, Med, and Biotech category. This honor is “awarded for the new […]
Truffles evoke a romantic image of foraging for fragrant unearthly treasures in ancient and wizened woodland. This may have been true in the past but today, that back truffle shaved onto your pasta is most likely to have come from a cultivated source. Truffles are fungi, but a very specific type of fungi that needs […]
Through her tenure at Signature Science LLC, Mary Heaton had seen the company’s portfolio of DNA applications grow hand-in-hand with the power of genetic technologies. Founded in 2001, Signature Science is engaged in the collection, analysis, and interpretation of DNA data for use in personal identification, including applications in homeland security, public safety, criminal justice […]
(. . . and much longer!) Myth: PCR product needs to be refrigerated if left overnight in the thermal cycler Truth #1: DNA will be stable for days, even weeks inside a PCR tube Truth #2: Extended cold holds will reduce your PCR machine’s lifetime Many scientists and other PCR users believe that samples need […]
Affordable biotech toolkit to enable hands-on DNA analysis in UAE classrooms CAMBRIDGE, Mass., Nov. 28, 2016 /PRNewswire/ -- Amplyus announced today the deployment of the miniPCR DNA Discovery System™in five high schools of the United Arab Emirates. The schools are finalists in the Genes in Space™ UAE competition inviting students to design DNA analysis experiments [...]
by Victoria Lin Sara Shayesteh was enjoying the time she’d spent so far as a high school biology teacher in the South San Francisco Unified School District (SSFUSD), but as the years passed she’d noticed something that worried her. The teens in her biology class at El Camino High School regularly performed labs that included […]
We live in the era of personal DNA technology, says miniPCR co-founder Sebastian Kraves. From improving vaccines to modifying crops to solving crimes, DNA technology has transformed our world. Now, for the first time in history, anyone can experiment with DNA anywhere: at home, in their kitchen, in classrooms, in the field, even in space. […]
New teaching tool: simple explanations of modern genetic technologies miniPCR is excited to announce the launch of DNAdots. DNAdots are bite-sized and simple explanations of modern genetic technologies. They will be freely available on our website as a teaching tool for anyone interested in modern genetics! Each DNAdot will cover a complex new genetic technology, […]
– This article was published in Biocoder on August 18th, 2016. Access the full article at O’Reilly Media. Three years ago, we set out to make personal DNA tools that everyone could use. miniPCR started as a maker project, and after a design and prototyping phase, we launched the DNA Discovery System on Kickstarter in […]
by Victoria Lin By all accounts, Ian Goodfellow would have been much safer had he stayed home rather than traveling to Sierra Leone in December of 2014. The country was in the middle of the worst Ebola crisis on record, and Goodfellow, a professor of virology at the University of Cambridge, had previously focused his […]
by Victoria Lin Sara Shayesteh was enjoying the time she’d spent so far as a high school biology teacher in the South San Francisco Unified School District (SSFUSD), but as the years passed she’d noticed something that worried her. The teens in her biology class at El Camino High School regularly performed labs that included building […]
This is an email sent this weekend to our team by happy miniPCR users in Mexico. Hello miniPCR Team, I hope everything is well on your side. I’d like to share through this message that, as I had mentioned before, we’ve held our first workshop in mitochondrial DNA (mtDNA) amplification, and it was a complete success. All […]
Practice gel electrophoresis with food coloring! This free lab is now available for download through this link. A kitted version of this Learning Lab is now available in the miniPCR store You may think that the technology used to match DNA samples, such as solving a crime by visualizing genetic fingerprints, is very complicated and […]
Astronauts are diving deep under the ocean to prepare for life in space This article by Rachel Feltman first appeared in The Washington Post on July 26, 2016 Some 62 feet under the seas of the Florida Keys, a band of astronauts — nay, aquanauts — are busy preparing themselves for life in space by living [...]
Student Wins Genes in SpaceTM Competition for Study of Aging in Space DNA analysis experiment to be performed aboard International Space Station San Diego, Calif., July 14th, 2016 – Genes in SpaceTM named Julian Rubinfien, a high school student from New York, the winner of the second annual Genes in SpaceTM competition. The innovative contest […]
This new video tells the story of miniPCR, told from the perspective of the team. miniPCR is a portable, personal, and accessible DNA Lab for everyone. In the words of the innovators behind miniPCR: “We were both passionate about the same problem… how to make genetics and DNA analysis accessible to everyone. So we decided […]
This guest blog post was contributed by Sarah Stahl, M.S., and Sarah Wallace, Ph.D., spaceflight microbiologists at NASA. Microbiological monitoring is an essential activity on the International Space Station (ISS). Microbiologists at the Johnson Space Center in Houston, TX, monitor the air, water, and surfaces of the ISS for microbial contamination to ensure a safe habitat for […]
See and touch DNA in your own kitchen or classroom! Download instructions for DNA extraction from strawberries using this link. Have you heard about prenatal DNA testing or about developing gene therapies? The news seems to be always talking about genetics, especially complicated concepts such as genetic testing, reconstructing evolution, synthetic biology, cloning, and other parts […]
This post originally appeared on PRNewswire on May 25th Experiment ushers in biotech era aboard International Space Station CAMBRIDGE, Mass. May 25, 2016 /PRNewswire/ -- miniPCR™ announced the first successful DNA amplification on the International Space Station (ISS). Using a miniPCR thermal cycler, astronauts performed Polymerase Chain Reaction (PCR) on DNA samples on April 19th. Analysis [...]
Sebastian Kraves Bring Hands-On, Affordable Biotech to “Everyone, Everywhere” with the miniPCR Machine Boston Consulting Group alumnus Sebastian Kraves [Boston, 2007–2013] has made DNA analysis more democratic. Sebastian helped invent the miniPCR, a machine that heralds a shift from academic science to citizen science, empowering everyone—from families, to school kids, to field scientists—to contribute to […]
This post originally appeared in the FedEx blog. FedEx is a sponsor of Genes in Space, the science competition organized by miniPCR and partners that invites students to design DNA analysis experiments for Space. Winning experiments are conducted aboard the International Space Station by astronauts using a miniPCR thermal cycler. Anna-Sophia Bougarev has been fascinated with space since […]
In 2015, 17-year-old Anna-Sophia Boguraev from Bedford, New York, won the inaugural Genes in Space competition. Boguraev’s experiment arrived at the International Space Station April 10, 2016, following an April 8 launch from Kennedy Space Center. Check out the video for more on Anna-Sophia’s story and the role of miniPCR, the first PCR cycler in space. […]
miniPCR thermal cycling technology is now on board the International Space Station. The Genes in Space 2015 winning experiment will be the first PCR experiment to be conducted on orbit, aboard the ISS. For a complete photo gallery of miniPCR launch aboard a SpaceX Falcon-9 rocket from Kennedy Space Center, please visit the Genes in […]
This article by Janelle Nanos appeared in the Sunday April 2nd, 2016, edition of the Boston Globe Magazine. For the complete article please click on this link. Amplyus goes to market with a cheaper, more portable DNA analysis device The mini machine helps researchers in far flung locations from Sierra Leone to outer space. For […]
KENNEDY SPACE CENTER, Fla., April 1, 2016 /PRNewswire/ — Anna-Sophia Boguraev’s (17) winning Genes in Space student experiment is scheduled for launch to the International Space Station (ISS) on April 8th from Kennedy Space Center (KSC) inFlorida aboard NASA’s Cargo Resupply Services flight (CRS-8). Her experiment will assess if changes in DNA can be detected […]
Whether due to bureaucratic red tape or the remoteness of the site, field researchers have long been plagued by the problem of how to bring the samples they collect back to a place where they can study them. Elaine Guevara was no exception to this rule. As a PhD candidate in biological anthropology at Yale, she made regular trips […]
NASA Highlights Array of Experiments Launching on Next SpaceX Cargo Mission (This Press Release issued by NASA highlights the upcoming launch of miniPCR to the International Space Station in the context of the Genes in Space-1 mission) WASHINGTON, March 24, 2016 /PRNewswire-USNewswire/ — NASA will host a media teleconference at 1 p.m. EDT Monday, March […]
Mosquitoes in the developing world are responsible for infections that threaten more than one billion people. But what if scientists could use those very mosquitoes to quickly identify a disease outbreak, and then quickly deploy the resources to stop it? A lab that fits in a backpack and includes miniPCR could be the answer. In this […]
Cutting Edge: Local inventors changing the way we analyze DNA We often hear about the analysis of DNA in TV crime shows, and it's also useful in fighting global outbreaks of disease. But DNA testing typically has to be done in a lab and taking time. But some local inventors are changing that. This featured appeared [...]
This article appeared in Bostinno on Feb 4th 2016, and the full feature can be accessed from their website This Harvard Startup Is Sending Its DNA Machine to Space MiniPCR – the startup that’s bringing DNA technology to the masses – has started to grow so much that it’s out of this world. Literally. The company will be sending one […]
This webinar was offered by The Biotechnology Center of Excellence on Jan 27th 2016, and can be accessed from their website Genes in Space & miniPCRTM The science of DNA has enhanced our society in unprecedented ways; it has been used to improve crops and help feed a hungry world, solve crimes with unparalleled accuracy, and […]
Here are the 15 DNA science events that captured our imagination in 2015. Enjoy! – Scientists from the US and UK have mapped the genome of the bowhead whale and identified genes responsible for its 200-year lifespan, the longest of any mammal. 7 January – In a world first, researchers from New Zealand have observed […]
Our team at miniPCR is excited to bring science into the hands of youth. We are passionate about translating complex concepts into hands-on experiences. Our hope is that, once equipped with tools and experiential opportunities, the younger generation of scientists will create a reality that is beyond our imagination. We were excited to launch the […]
Student DNA Experiment Selected as Winner of Genes in Space Science Competition Experiment to be performed aboard International Space Station Boston, MA, July 8th, 2015. Boeing, the Center for the Advancement of Science in Space (CASIS), Math for America (MfA), and miniPCR named Anna-Sophia Boguraev from Bedford, NY, the winner in the first ever Genes […]
Five Student Teams Selected as Finalists for International Space Station Science Competition Winning Genes in Space DNA experiment to be performed aboard ISS New York, NY, June 1, 2015. Boeing, the Center for the Advancement of Science in Space (CASIS), Math for America (MƒA), and miniPCR named five finalists in the first ever Genes in […]
PCR heads into the field 2015 has so far been a breakthrough year in our mission to make DNA science accessible. Among other news, we’ve partnered with the International Space Station to put miniPCR in orbit, inviting students to propose and design the first DNA amplification experiment in space through an exciting competition. In addition, […]
Winning team will have DNA experiments performed aboard the International Space Station Cambridge, MA (March 19, 2015) — Today, miniPCR and Math for America (MƒA) announced Genes in Space, an innovation challenge that invites teachers and students in grades 7 through 12 across the nation to design a pioneering DNA experiment for space. Participants are […]
This is a guest post by Aspen Padron, senior at James C. Enochs High School in Modesto, California. Aspen is working on her senior honors thesis under the leadership of Mr. Dave Menshew, MA.Ed. NBCT, in the Forensic/Biotechnology Career Pathway Program. Below is an account of Aspen’s first genetic barcoding experiment using miniPCR. Recently I […]
Here goes our love and gratitude to supporters of DNA education who backed miniPCR on Kickstarter, pledging $5 or more just for the fun of supporting science education. Thanks to you all for letting the world know you care about DNA!! PS: If you have pledged at a different pledge level, and would like us […]
We have just successfully closed our Kickstarter campaign. miniPCR is officially funded! THANK YOU to the 245 backers who believed in us and are supporting our project to bring DNA science to everyone, everywhere. Thank you to friends, mentors, miniPCR users, colleagues, spouses, and families who contributed ideas and support throughout the campaign. Today is […]
BioCoder is the self-described newsletter of the biological revolution. And miniPCR is the poster child (of the 2014 Fall issue, that is)! Check it out here. BioCoder is about biology as it moves from research labs into startup incubators, hacker spaces, and even homes. It’s about a very old programming language that we’re just beginning […]
Science educators invest heavily in their students: creating learning experiences and supporting their students all year long. To support those experiences, it is critical to help teachers and schools find the funding they need to invest in students. Below is a brief list of STEM funding resources, compiled by various organizations that took a comprehensive […]
Source: https://www.masslifesciences.com/programs/equip The STEM Equipment and Supplies Grant Program enables the purchase of equipment and supplies for High Schools and Middle Schools in the Commonwealth in order to train students in life sciences technology and research, as well as addresses a funding gap in capital dollars for public and not-for-profit workforce training and educational institutions. […]
Alia Qatarneh is the lead research assistant at Harvard University’s Life Sciences Outreach Program, which works with high school teachers and students from across New England. Alia authored the post we reproduce below on her blog on 9/2/2014.. NOTHING MINI ABOUT THIS MACHINE I had the pleasure of meeting Zeke and Sebastian over one year […]
Cambridge, Mass. – When you think of summer camp for kids, you think of the great outdoors, swimming in lakes, and roasting marshmallows by the campfire. But have you heard of a camp that has kids explore the molecular underpinnings of life? Or study DNA by performing the polymerase chain reaction? This is not your […]
Educators and entrepreneurs recently spent a day exploring the future of learning and teaching at the Beta Teacher event hosted by EDC. We were lucky enough to join 20 other education technology startups and an engaged crowd of teachers interested in expanding the technological horizons of their classrooms. Please read the brief article directly on […]
Today we’re unveiling the miniPCRTM machine video. We’re hoping you will help us reach more people in more places and bring them DNA technology that was until now too difficult, too cumbersome, and too expensive. So help us spread the word: tweet, blog, repost, link, and microblog it. Help us keep making DNA science simpler […]
Excerpts from the very nice piece describing stories from Rockefeller University’s recent science fair, with big thanks to Jeanne Garbarino… Dr. Ezequiel Alvarez Saavedra, one of the volunteers for MiniPCR, described this story: “I had a girl, maybe 7 yrs old, come by the table that left me very impressed by her persistence. I started […]
We are constantly working to make science simpler, more accessible, and more convenient. Today we’re testing the first beta release of the miniPCR mobile app. We started this development with two simple goals in mind: convenience and interactivity. In today’s world, why can’t we control our biotech experiments with the same convenience smartphones and tablets […]
We want to disseminate the meaningful work that Ilio Durandis and team at the Haitian Bioscience Initiative recently jump-started with their pilot in Haiti. A nice video documenting the comprehensive training meant to prepare and inspire the next generation of Haitian bioscientists. Congrats to Ilio and HBI team! No doubt this impactful program will continue […]
The miniPCR team is just back from an inspiring week of science education in the San Francisco Bay Area. We were generously invited by BABEC, the Bay Area Biotechnology Education Consortium, a regional network of local science education organizations based in the Northern California Bay Area. BABEC serves close to 400 teachers in over 200 […]
Our mission is to bring DNA science to more people in more places. That’s why we’ve designed miniPCR to be portable, affordable, and travel well. miniPCR’s most recent destination has been Haiti, where it joined the pilot of the Haitian Bioscience Initiative between May 26th and 30th, 2014. The initiative seeks to train young Haitians […]
Today we found out that our company Amplyus has been selected to join the 2014 MassChallenge Accelerator program. We are excited, humbled, and grateful at this honor. Excited because this represents a unique opportunity to keep growing this project that brings DNA technology to many more people in more places. Humbled by the amazing fellow […]
What a fantastic time we had at the recent National Science Teachers Association national conference in Boston. We met inspiring educators, re-connected with old friends, and soaked in the vibrant atmosphere that surrounded the conference. We only wish we had had more time there. We were also humbled by the energizing reception you all gave […]
We are thrilled at the formal announcement of our collaboration with partners MassBioEd (the Massachusetts Biotechnology Education Foundation) and New England Biolabs to make PCR more accessible to students and teachers. The three-way collaboration brings content, technology, and reagents into the hands of teachers eager to implement biotechnology labs. Together, we’ve created a self-contained module […]
Wow. We really appreciate all the love and support we are receiving from teachers. NSTA is exhilarating — not much time to blog amidst all the talks, workshops, and cool new tools showcased, but we’ll be back soon with some reflections once the dust starts to settle. Meanwhile, enjoy the show!
We founded Amplyus with the dream of increasing access to science education. The specific question in our minds has long been: How do we create memorable DNA experiences early in the lives of students? Yesterday we took a small step in that direction. At a professional development workshop organized by MassBioEd (the Massachusetts Biotechnology Educational […]
I don’t remember what led to them, or what happened right after. But I remember each of these moments vividly, crisply, like I am frozen in them. These moments are all my firsts in biology: my first animal dissection (yuck), my first DNA extraction (thrill), my first PCR band on a gel (awe), my first […]
We are so excited preparing for the NSTA National Conference in Boston next month (April 3-6). Over 10,000 attendees from across the country and so many cool exhibits, events, and even cool field trips to Boston’s Science Ed hubs. Come find us at the Amplyus booth – booth 1336 (see here for a complete list […]
Last week we had an inspiring conversation with Natalie Kuldell, founder of BioBuilder. Natalie teaches at the Biological Engineering Department of MIT, where she ensures the next generation of bio engineers will be engaged, energized, and avid problem-solvers — and not followers of “cookbook science protocols”. Seems like an easy task for her – a […]
We spend a lot of our time talking to science teachers. It is inspiring to find how many of them go out of their way to inspire and stimulate their students. For example, many biology teachers in Massachusetts partner actively with science outreach groups to bring molecular biology and new teaching technology to their classrooms. […]
We are constantly looking for ways to support science education. miniPCRTM lab protocols are one of these ways. They are meant to help high school students grasp theoretical concepts in molecular biology, while gaining hands-on biotechnology experience. They are also meant to facilitate curriculum and lesson planning for science teachers. We found through our work […]
Modern biology is grounded in DNA analysis and its modification. DNA amplification through the Polymerase Chain Reaction (PCR) is an essential step in virtually every biotechnology application, including cloning, sequencing, diagnostics, crop improvement, medical genetics, forensics, and many others… In the genomics era, no STEM curriculum is complete without including the theory, and ideally the […]
Last Fall, students at Greater New Bedford Regional Vocational Technical High School (GNBVT) learned how to complete PCR laboratory experiments. The teaching team (Scott Atkinson, Pam Baptiste, and Aimee O’Neill) has been enabling junior and senior classes at GNBVT to build robust molecular biology skills. They learned about miniPCR machines through MassBioEd’s BioTeach program that […]